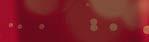

![]()







































































































































































































Zó zacht, Zó romig. Probeer nu!















































12 Interview Huub Stapel
22 Society Journaal
28 Columnist Rob Goossens
60 7 vragen aan Botan Takada
64 Tai Chi Walking
20 Hip & Hot
42 Koken met Sharon en wijnadvies van David
48 Reizen: de Vogezen
54 Eropuit
56 Sietskes Oogappels
68 In de Hoofdrol: Tina Nijkamp
32 Huishoudbode
38 Groen geluk
76 met














76

7 VRAGEN AAN...
60
Intiem met Lieve
82 Dierenwereld

12
‘Mijn moeder zag mijn vriendin op Tinder’



Winnares 2025 Botan: ‘Doe mee aan het Concertgebouw Concours!’

DenD interviewt
Huub Stapel: ‘Ik ben opgevoed door de leukste vrouw van de wereld’








86 Kits mee Concertg Concour









48 Vogezen en Elzas: twee voor de prijs van één






68

Hilversum siddert voor kijkcijferkoningin Tina r a

64





Wasbordje in zeven minuten, geloof jij het?


Nog geen drie jaar geleden liep Margot Robbie de wereld over als Barbie. Nu staat ze op een winderige heide als Cathy in Wuthering Heights. De sfeer is totaal anders. Barbie was één grote roze bubbelgumfantasie, deze film is donker, romantisch en wild. Ook haar stijl ging volledig mee in dat verhaal. Tijdens de hele perstour verscheen ze in korsetten, fluweel en jurken die lijken alsof ze al honderd jaar in een Engels kasteel hangen. Hollywood heeft daar zelfs een term voor: ‘method dressing’. Je kleedt je zoals je personage.
Terwijl zij zich druk maken over korsetten en rode lopers, spraken wij een acteur die al veertig jaar laat zien hoe het vak hier wordt beoefend: Huub Stapel. Hij staat opnieuw op het podium met Mannen komen van Mars, Vrouwen van Venus. Volgens hem is er de afgelopen vijftien jaar bar weinig veranderd. De planeten staan nog steeds regelmatig op ramkoers en Mars zit nog altijd vol mannen.
Verder: de terugkeer van Harry Styles in Amsterdam. Expert Lieve buigt zich over een ongemakkelijke vraag uit de liefdeshoek, eentje waar een Tinder-account en een oplettende moeder in voorkomen. We nemen je mee naar de Vogezen en de Elzas. Tot slot testen we de fitnesshype die belooft dat je met een paar minuten beweging per dag een strakkere buik krijgt. Klinkt mooi. Wij zijn benieuwd.
Veel leesplezier,
Anette de Vries


Elke maand meer dan 3,5 miljoen kijkers!










Zet DenD in je beginscherm!
Wil jij ook op deze pagina verschijnen?
Stuur een e-mail naar: commercie@trustedmedia.nl

Zandsculpturen Garderen presenteert een gloednieuwe tentoonstelling over het Romeinse Rijk. Ontdek meer dan 100 scènes, levensgroot in zand, gemaakt door internationale topkunstenaars. Loop langs keizers, legioenen en het dagelijks leven van toen, met decor en beplanting die alles tot één beleving maakt. zandsculpturen.nl
DenD verloot 6X 2 tickets voor Zandsculpturen Garderen, plus koffie met appeltaart. Ga naar ditjesendatjes.nl/ winnen.

Wil je dit jaar eens iets anders dan bloemen of parfum? Denk aan een middag buiten, samen aan de wandel met een alpaca. Je begint met een high tea. Daarna krijg je een korte uitleg en ga je zelf op pad met een alpaca aan de lijn. De route voert langs mooie plekken in de omgeving, met genoeg tijd voor foto’s. Alpaca’s zijn rustig en lopen als kuddedieren netjes met elkaar mee. Het uitje is op meerdere locaties en duurt ongeveer 3 uur. good4fun.nl
WINNEN!
DenD verloot eenGood4Fun-vouchereenvoor alpaca-wandeling met high tea.Ga naar ditjesendatjes.nl/ winnen.

Opvliegers op Safari is een vrolijke vriendinnenkomedie in het theater, met muziek en veel herkenning. Vier vrouwen gaan samen op reis, en tussen safari’s en wijnproeverijen door lopen ze vooral tegen zichzelf aan. De één rekent af met mannen die haar hebben teleurgesteld, de ander wordt verliefd op een 71-jarige. Met Linda Wagenmakers, Alexandra Alphenaar, Joanne Telesford en Nicole Berendsen. Te zien door heel het land tot en met 14 juni. repentertainment.nl
WINNEN! DenDgeeft2X Opvliegers2ticketswegvoor opSafari . Ga naar ditjesendatjes.nl/ winnen.
DenD verloot 1X 4 kaarten voor Moeder de Gans in HetConcertgebouw + een overnachting met ontbijt in het Volkshotel (gezinskamer). Ga naar concertgebouw.nl/ditjesendatjes om kans te maken.
Begin deze Moederdag, na dat ontbijtje op bed, met het hele gezin in Het Concertgebouw. Tijdens Moeder de Gans(6+) komen de sprookjes tot leven op Ravels muziek, met onder meer Doornroosje en Klein Duimpje, gespeeld door het Noord Nederlands Orkest. Plak er een nachtje Amsterdam aan vast in het Volkshotel, het voormalige Volkskrantgebouw aan de Wibautstraat in AmsterdamOost. Je zit er lekker centraal, vlak bij de Amstel en De Pijp, met de metro om de hoek.


Avonturenpark De Tovertuin is nét open in Hoogerheide, vlak bij de Belgische grens. Het zit op de plek van het oude vakantiepark Familyland en is nu helemaal Woezel en Pip, maar dan op peuterformaat: overzichtelijk, rustig en vooral veel spelen. Je vindt er ruim 25 attracties en shows, en er is een grote indoor speelhal van 3000 m². Wie er meteen een mini-vakantie van wil maken, kan ook blijven slapen bij Familie Resort De Tovertuin. avonturenparkdetovertuin.nl
WINNEN!
DenD verloot 1X 4 kaartjes Avonturenparkvoor De Tovertuin. Ga naarditjesendatjes.nl/ winnen.

WINNEN!
DenD verloot 10 exemplaren van Harry Potter en het Vervloekte Kind Ga naar
DenD.nl/winnen om kans te maken.


19 jaar later... Het verhaal van Harry, Ron en Hermelien gaat verder waar de magie werkelijkheid wordt: in het theater! Bereid je voor op toverspreuken, een verbluffende race door de tijd en een epische strijd om mysterieuze krachten te stoppen, terwijl de toekomst op het spel staat. Een speciale editie van het boek Harry Potter en het Vervloekte Kind met de volledige toneeltekst. deharmonieharrypotter.nl














































































Huub Stapel is terug in het theater met het onderwerp dat hem vijftien jaar geleden volle zalen opleverde: 'mannen versus vrouwen'. Met DenD spreekt hij over het 'reptielenbrein' van de man; het ontbreken van fatsoen in de maatschappij en over de gang van zaken in het huishouden. Ook onthult Huub waarom hij het vaker opneemt voor vrouwen dan voor mannen.




Als rechercheur in de Amsterdamnedgrachtenklassieker(1988).

Huub Stapel (71) loopt zich in Oldenzaal warm voor de try-out van zijn theatertour: Mannen komen van Mars, Vrouwen van Venus – het onvermijdelijke vervolg. Vijftien jaar geleden speelde hij het stuk 473 keer. Het publiek kreeg er geen genoeg van. Nu is hij terug. DenD spreekt Huub kort voordat hij het podium betreedt.
Waaromditvervolg?
„Omdat het na al die jaren veel actueler is dan wij dachten. In Parijs speelden ze vorig jaar een opgepoetste versie. Daar liep iedereen weer voor uit, in de leeftijd van 14 tot 94 jaar. Toen dachten mijn vrouw en ik: als je dit opnieuw tegen het licht houdt en je laat het samen met Peter Heerschop en twee dertigers herschrijven, dan moet het hier ook weer kunnen. En tot nu toe is het enthousiasme net zo groot.”
Wat moest er anders?
„Er zaten dingen in die typisch waren voor 2009 tot 2016. Die hebben we aangepast. De tijd is veranderd, er is meer nuance. We ontdekten dat vrouwen soms
‘WE ONTDEKTEN DAT VROUWEN SOMS OOK VAN MARS KOMEN EN MANNEN SOMS VAN VENUS’

mann n en n somms s n Veenunus. s e s r ar a t-wiwit t da d n we et t to toen spe p e eldeden. n
Dus er is minder veranderd dan we misschien denken?
„Ik las in de Volkskrant een column van Doortje Smitshuijzen. Zij schrijft dat bij het samenwonen alle zorg automatisch op haar neerkwam. Zij regelde de wijn, het eten, betaalde de schoonmaakster. En als ze haar vriend vroeg of hij de ijskast kon uitruimen of de vuilniszak buiten kon zetten, kreeg ze te horen: 'Zo werkt mijn brein niet.' Dat was voor mij het ultieme bewijs. Die column haal ik ook aan in de voorstelling. Dan denk ik: Het is gewoon dat oerbrein van de man. Dat reptielenbrein dat nog steeds hetzelfde werkt en vindt dat vrouwen niet helemaal gelijk zijn aan de man.”
Bijuthuisisdatanders?
„Bij ons zijn we in het huishouden volkomen gelijkwaardig. Dat is gewoon zo. Alleen is dat nog niet overal het geval.” ➜

k m V zw h M zi pr p ve v en
Maaar a in n de pra r kt k ijjk k e je vaaaak k no n g st s eeeds ds rec e ies s deze z lf l de d erddellin i g terug.”
ook van Mars komen en mannen soms van Venus. Het is minder zwart-wit dan we het toen speelden. Maar in de praktijk zie je vaak nog steeds precies dezelfde verdeling terug.”









Stapel op zijn vriendin Annemiek.
Huub Stapel (1954) debuteerde in 1983 in De Lift en speelde sindsdien in meer dan dertig toneelstukken en ruim 120 films en series. Hij brak door met Flodder en Amsterdamned en was jarenlang een vaste waarde in Flikken Rotterdam. Nu is hij te zien in Amsterdamned II, Boomers en Champagne. Eerder stond hij in het spektakel Het Geluk van Limburg. Daarnaast werkt hij aan een nieuwe reeks van Het Dorp met Wim Daniëls en draait hij Nederland van Boven voor Omroep MAX. Huub woont in Amsterdam met zijn vriendin Annemiek de Vroeg. Uit zijn vorige relatie heeft hij twee kinderen, Sem en Mas. Hij is opa van twee kleinkinderen.
Bent u zelf ooit zo’n klassieke Mars-man geweest?
„Nee. Zo ben ik niet opgevoed. Ik moest leren strijken. Mijn moeder vond dat ik ook moest kunnen breien en stofzuigen.”
Maarbijveelmannenleeftdat oudepatroonnogsteeds?
„Ja. Zoals de oermens, zo doet de man nog steeds. Niet iedere man, maar het is wijdverbreid.”
Isdatreptielenbreinniet slechts een alibi om niks te doen?
„Natuurlijk is het een smoesje. En dan moet je daar als vrouw tegenin gaan. Je hoeft als vrouw niet alles te accepteren.”
Hijziethetindezaalgebeuren.
„Van de mensen die tijdens de voorstelling uit hun stoel vallen van het lachen, krijg ik het gevoel dat het nog erg veel voorkomt.”
Watdantedoen,zonderin gezeurofdwangtevervallen?
„Met elkaar in gesprek blijven. Geven wat de ander nodig heeft, niet wat je zelf wil krijgen. Dat




herhaal ik in de voorstelling.


Zij j lif b bi i in n


Zijn filmdebuut in de liftthriller die hem bij het grote publiek introduceerde (1983). k telling. het t p
Geef de ander wat hij nodig heeft.”
Kunt u dat concreet maken?
„Ik geef één voorbeeld, anders moet je komen kijken. Er liggen spullen op de trap. Tandpasta, shampoo, conditioner, maandverband. De meeste mannen denken: wie legt die rotzooi daar neer, ik kan mijn nek breken. Het komt niet in hen op dat het daar ligt om mee naar boven te nemen. In die zin zitten mannen nog steeds in oude rolpatronen. Mannen moeten worden Gerewired en hergeprogrammeerd.”
Door wie?
„Door henzelf.”
Uwiltzeduseenschoponder dekontgeven?
„Ze krijgen in de voorstelling ook een schop onder de kont.”
En de vrouwen?
„Ook. Maar ik moet bekennen dat ik het vaker opneem voor de vrouw dan voor de man. Omdat



ik zelf een man ben. Dat is een opdracht van thuis.”
Waarommoetuhetjuist voor vrouwen opnemen?
„Mijn stem is voor mannen én vrouwen acceptabel. Als een vrouw precies dezelfde tekst zou zeggen, waren veel mannen niet gekomen.”
Of zewarenweggelopen.
„Dat gebeurt nu ook weleens. Er loopt soms een man weg die niet



tegen zijn verlies kan, of ontdekt dat hij geen gevoel voor humor heeft. Soms ook gewoon omdat hij in de pauze voetbal wil kijken. Maar vrouwen lopen nooit weg. Dat is het gekke. Vrouwen voelen zich altijd aangesproken. Ik denk eerlijk gezegd ook dat vrouwen meer gevoel voor humor hebben.”
U kiest dus bewust hun kant. „Dat komt omdat ik ben opgevoed door de leukste vrouw van de wereld. Bij ons thuis was het
normaal dat ik meedeed in het huishouden. En gewoon fatsoen. Als je ergens gaat spelen zeg je: 'Wat fijn dat ik hier mag spelen.' En als je weggaat zeg je: 'Dankjewel.' Simpele basisregels.”
Hijdenktevenna.
„Als ik zie hoe mijn vader met mijn moeder omging, dan heb ik daar veel van opgestoken.”
Watzagudan?
„Respect. Elke vrijdag bloemen
‘ IK DENK DAT VROUWEN MEER GEVOEL VOOR HUMOR HEBBEN DAN MANNEN’
meenemen. Niet omdat hij dat moest, maar omdat hij haar enorm hoog had zitten. Zo ben ik opgevoed. Met een sociaal kompas. Dat je weet hoe je je moet gedragen. In huis en in de publieke ruimte. Daar kun je de wereld mee over.”
Zietudatterugbijuwzonen?
„Natuurlijk. Ik zie hoe Sem met zijn meisje omgaat, op basis van totale gelijkheid. Ze zijn echt met elkaar in gesprek, nemen
➜










elkaar serieus. En ik zie hoe respectvol hij met zijn kinderen omgaat, dat hij ze regels en waarden bijbrengt...”
Watstoortuindesamenleving?
„Gebrek aan fatsoen. Rondrennen in restaurants. Grote monden. Ik sta in de supermarkt en zie een kind zijn moeder tegen de schenen schoppen. Dan denk ik: van wie heb je dat geleerd?
Geen dankjewel. Geen rekening houden met anderen.”
Uheefthetsteedsoverrespect. Hoe werkt dat in de liefde? Zit romantiek dan in bloemen?
„Je wilt eigenlijk dat ik je de hele voorstelling voorkauw”, lacht hij. „Maar dat ga ik niet doen. Daarvoor moet je komen kijken. Alles wat je noemt zit erin.”
Alsrespectdebasisis,wat vindt u dan van mannen die hettegenovergestelde prediken,zoalsdeomstreden influencer Andrew Tate?
„Daar wil ik eigenlijk niets over zeggen. Ik vind dat verschrikkelijk. Onopgevoed. Ik zou bijna zeggen: verzuip die gast, maar dat is nog te veel eer. Dat jonge mannen hem als voorbeeld nemen is zorgelijk. Dan heeft niemand je geleerd hoe het hoort.”

Isernogietsovervandat
Zwitserlevengevoel?
„Nee. Op de bankrekening niet.”
Gevoelsmatigdan?
metAnnemiekdeVroeg.Zijn erplannenomtetrouwen?
Uwshowstaatdaarhaaksop.


„Ja. Maar die jongens komen niet naar mijn show. Die gaan naar iets waar wordt geroepen dat je je meisje moet slaan als ze niet doet wat jij wil. Flikker toch gauw een eind op, zeg.”

Ooitzatuop eenbankjein de zon voor de Zwitserlevencampagne, met Ellen ten Damme.
atdaarhaaksop. ongens komen show. Die waar wordt e je meisje s kker toch gauw eg.” -













Ik ben anderha thuis geweest. Me meisje op vaka is er no Maar het zit m hoofd op Als ik thuis ga niks meer ik ong vo geen U a v j
„Jawel. Ik ben anderhalve maand thuis geweest. Met mijn meisje op vakantie. Dat gevoel is er nog wel. Maar het zit meer in mijn hoofd dan op de bank. Als ik thuis ga zitten en niks meer doe, word ik ongelukkig. Ik voel me geen 71 jaar.”


U bent alweer zo'n veertien jaarsamen



„Nee. Ik word er niet gelukkiger van. Het huwelijk is ooit uit economische belangen ontstaan, niet uit romantiek. Ik ga niet nog een keer trouwen.”
Voelt verliefdheid anders oplatereleeftijd?
„Verliefdheid is verliefdheid. Natuurlijk verandert het door levenservaring. Je bent ouder, je weet meer. Maar beter? Nee. Niet beter.” ■
MannenkomenvanMars, Vrouwen van Venus–het onvermijdelijkevervolg is t/m 27 juni te zien in heel Nederland.








































































































De dikke truien kunnen naar zolder, de maillots onderin de la: het is lente! En dat betekent vrolijke jurken, zwierige rokken en luchtige broeken. Wat heeft het nieuwe modeseizoen voor ons in petto? Veel lichte, soepel vallende stoffen, die perfect passen bij de stijgende temperaturen. Net als bloemenprints, hét dessin voor zonnige lentedagen. De rokken zijn dit voorjaar groot en opvallend, met extra stof of textuur. En terug van nooit echt weggeweest is de kostschoolachtige, klassieke preppylook.
Knalkleuren
Ook zien we veel franjes die zorgen voor een vrolijke uitstraling. Vooral tassen met franjes zijn helemaal hot. Draag jij alleen op Koningsdag en tijdens voetbalwedstrijden oranje? Dat gaat veranderen, want oranje is dé kleur van nu. Ben je geen fan van oranje, maar wel van felle kleuren, ga dan voor die andere modekleur, fuchsia. Maar ook blauwgrijs, pastels en aardetinten zien we veel dit voorjaar. Sneakers en ballerina’s maken plaats voor klassiek
ballerina’s maken voor klassiek schoeisel zoals loafers en mocassins.



Een witte blouse, een sportieve trui of spencer en een blauwe blazer zijn onmisbare items voor de klassieke en altijd stijlvolle preppy kledingstijl. Van Part Two.


Move over sneaker, dit seizoen l op klassiekers zoals m en loafers. Deze stoffen loa casual in co jeans of een p
Move over sneaker, dit seizoen lopen we op tijdloze klassiekers zoals mocassins en loafer van Mou draag je casual in combinatie met jeans of stijlvol onder een pantalon.

Met deze gebloemde rok van Essential Antwerp ga jij zwierig het voorjaar tegemoet. De rok in een relaxte A-lijn is volledig gevoerd, valt soepel en heeft onopvallende steekzakken.







Met deze suede tas van Unisa ben jij helemaal on trend dit voorjaar. De vrolijke franje tas heeft een stoffen voering en luistert naar de naam Camello.








Je hoeft niet te wachten tot Koningsdag om je in oranje te hullen. Ook op een gewone doordeweekse dag voel jij je koning te rijk in dit leren jasje van Alysi.
Of je nu naar je werk gaat of naar een feestje, met deze Torya pantalon van Mart Visser zit je altijd goed. De pantalon met hoge taille is gemaakt van een soepele stof met lichte stretch. Lekker comfortabel dus.























































Je weet dat een film raak is als niet de dialoog, maar Margot Robbies blush blijft hangen. Wuthering Heights is een absolute wereldhit met ruim 80 miljoen dollar opbrengst.

























Met Jacob Elordi bij de première van HeightsWuthering in Londen. , gten,

g n.







uthering Heights, bij

Woeste Hoogten is een van de grootste liefdesverhalen ooit, en regisseur Emerald Fennell maakt er een dampende filmversie van.

Daarna zette ze de crème licht vast met een flinterdun laagje losse poeder en kwam er nog poederblush overheen, om het zachter en egaler te maken.
Margot Robbie speelt Cathy, Jacob Elordi is . Hun romance begint romantisch, maar slaat al snel om in obsessie en wraak, met de Yorkshire-heide als decor. Na de première verschoof de aandacht razendsnel van het verhaal naar één detail: Robbies dieproze, windgeslagen blush. Die kreeg al snel de bijnaam 'Brontë blush' en ineens wilde iedereen die look.
utheri ons W is een veerhalen ooit, en m maakt er een da M Robbie Heathcliff. Hun m maar slaat al sn m met Yorkshir prremière versch vaan diieproze, windg al l snel de bijnaa d
Het werd pas echt een ding

Zachter en Heet werd pas ec tooen Dubro m artist v u uiitlegde hoe ze haad Ze
Chhanel N°1 Lip a Baalm Cam
B Berry Boost en met een kwast omla zo als een ‘p wangen
Pati Dubroff, de vaste make-up artist van Margot, uitlegde hoe ze die blush had gemaakt. Ze mengde Chanel N°1 Lip and Cheek Balm in Red Camellia en Berry Boost en blendde de kleur met een foundationkwast omlaag en naar buiten, zodat het niet als een ‘plek’ op de wangen blijft zitten.



Vanaf dat moment werd de Chanel-balm ineens een lastig te vinden item; iedereen op alternatieven.
De één wilde een exacte dupe, de ander vooral dezelfde glans en berry-kleur voor minder geld, en overal verschenen korte stappenplannen om ‘Brontë blush’ thuis na te maken. Op social media gingen #WutheringHeightsMakeup en #MargotRobbieBlush door de miljoenen views, en de dupes waren vaak net zo snel uitverkocht. In de beautywereld werd het al snel de sexy blush-trend van 2026 genoemd.
Tijdens de premièretour bouwde Robbie haar rode-loperlooks rond dezelfde donkerromantische sfeer, met kleine knipogen naar Wuthering Heights in styling en details. Daardoor ging het al snel niet meer alleen over haar blush, maar ook over haar outfits. Sexy Yorkshire Goth’ werd de bijnaam van de tour, en de korsettrend paste daar perfect bij, omdat ze steeds voor ingesnoerde silhouetten koos, van gala tot jeans.
In Sydney geen strak korset, maar gewoon een wit T-shirt.


rom kn
He

Da m m ‘S d d p v k

Styles is terug met zijn vierde album Kiss All The Time. Disco, Occasionally.

Laat de popster zich straks op de Amsterdamse grachten zien?




De zanger gaf in 2023 zijn laatste NL-shows in de ArenA.




In mei en juni staat Harry Styles tien avonden in de Johan Cruijff ArenA. Amsterdam is zijn enige halte op het Europese vasteland. Parijs ontbreekt, net als Berlijn en Madrid. De kaartverkoop veroorzaakte een digitale stormloop; honderdduizenden mensen stonden in de wachtrij en binnen enkele minuten waren de eerste tickets verdwenen.
De tour heet Together, Together en telt slechts zeven steden wereldwijd: Londen, Amsterdam, New York, São Paulo, Mexico-Stad, Melbourne en Sydney. Wie hem Harry Styles zien, moet reizen. Fans uit België en Duitsland boeken vluchten en treintickets. 'Hij gaat niet op tour, zijn fans wel', klinkt het op sociale media. De prijzen zijn niets voor gevoelige portemonnees. Voor een staanplaats in Amsterdam betaal je tussen de €141,37 en €315,28. Zitplaatsen beginnen bij €74,05 en lopen op tot





€319,37. Voor een VIP-avond tik je €828,62 af. En dan moet je trein of hotel nog worden geboekt. Sommige fans noemen de prijzen voor de Together Together-tour ‘hebzuchtig’ en ‘wereldvreemd’. Toch zijn alle avonden uitverkocht. Schaarste verkoopt. Zeker als je drie jaar uit beeld bent geweest. Na 173 shows van Love On Tour trok Harry Styles in 2023 de stekker eruit. Dat besluit had een voorgeschiedenis. Eerst de ontdekking van zijn talent door The X Factor in 2010, het succes later van One Direction, de band waarmee hij doorbrak naast Zayn Malik, Louis Tomlinson, Niall Horan en Liam Payne, maar ook het uiteenvallen van de band hakte erin. Over zijn eerste optredens zonder de groep, zei hij: „De eerste keren dacht ik: wat moet ik met mijn handen? (...) Ik voelde me ineens heel alleen.”
Harry Styles was dankbaar voor het succes, maar hij legde zichzelf ook een enorme druk op om alles perfect te doen. Dat perfectionisme, samen



















































met die eenzaamheid, sloop erin. Na Tour trapte hij daarom bewust op de rem om ‘langzamer te leven’. Hij noemde het zijn ‘ja-jaar’: ja tegen vrienden, ja tegen reizen, ja tegen het gewone leven. Harry werd in Londen gespot op een Lime-fiets, hij liep de marathon van Berlijn en stond bij Glastonbury tussen het publiek, waar normaal voor hem wordt gegild. Over die periode in zijn leven zei hij later: „Via mijn vrienden leerde ik weer dat een maaltijd meer is dan bijtanken.” En ook: „Het plezier zit in het moment zelf, niet in de haast eromheen.” Harry ontdekte voor zichzelf hoe lang het geleden was dat hij van iets alledaags als een gewone kop koffie had genoten.
Slimme rekensom
Misschien verklaart dat ook zijn huidige koers. Tien avonden in één stadion voelen
op erin. Na Love On wust oemde het reizen, ja tegen het in gespot de marathon van nbury tussen het or hem wordt zijn leven zei eerde ik weer dat ijtanken.” En ook: ment zelf, niet arry ontdekte ags k elen


Nieuwe look, nieuwe single: Aperture.
niet als toeval, maar als iemand die het anders wil aanpakken. Niet meer stad na stad, nacht na nacht in een nieuw hotel. Dat geeft rust. En ja, het is ook gewoon een slimme rekensom. Wie op , bespaart miljoenen aan transport en opbouw.
Romances

niet als maar als iema wil Niet meer sta nacht in een nieuw hotel. Dat het is ook gewoon een slimm één plek blijft, besp transport en opbo



Die behoefte om b po een stuk selec Na Olivia Wilde v romances me Rata Taylor Ru wordt g met Zoe K opvalt, zelf o wat h res
e om het overzicht te houden, zie je bij Harry Styles niet alleen op het podium. Ook privé lijkt hij een stuk selectiever geworden. volgden kortere romances met onder anderen Emily Ratajkowski en Taylor Russell. Inmiddels wordt hij geregeld gezien Zoe Kravitz. Wat vooral opvalt, is hoe weinig hij er zelf over zegt. Hij laat zien wat hij wil laten zien, de rest blijft van hem. ■











































































































Wie weleens naar de showrubrieken kijkt, weet dat Dubai even slecht scoort op smaak als op mensenrechten. Wonderlijk genoeg lijkt iedereen die weleens in diezelfde showrubrieken voorbijkomt, daar toch niet van op de hoogte. En dat is ergens ook wel weer fijn: het helpt namelijk om randfiguren als YouTuber Gio Latooy in het juiste afvalbakje te plaatsen.
Niet vaak kan ik Donald Trump ergens de schuld van geven. Dus nu ik het fenomeen Gio Latooy aan u moet introduceren, en dat daadwerkelijk door The Donald komt, grijp ik mijn kans. Want als Trump niet had besloten om de Iraanse ayatollah Khamenei uit zijn tulband te schieten, had de YouTuber, daar kortweg ‘Gio’ genoemd, niet met zijn gezin vastgezeten in Dubai. En als Gio niet had vastgezeten in Dubai, hadden we niet geweten dat zijn vriendin denkt dat ChatGPT een serieuze nieuwsbron is. En als zijn vriendin… afijn, laten we een beetje zuinig zijn met de context, want u begrijpt waar we heen gaan.
Numoet ik wel bekennen dat ik Gio klaarblijkelijk boos had gemaakt in een televisie-item over de eerste repatriëringsvlucht van KLM naar het Midden-Oosten. Ik heb het over de ‘jammerende BN’ers’ aldaar gehad, zonder ook maar één naam te noemen, en blijkbaar merkte de YouTuber dat de schoen zo goed paste dat hij hem meteen maar aantrok. Het gevolg was een woedend filmpje op Snapchat waarin hij aankondigde nooit meer op verzoeken van televisie-programma’s in te gaan. (Mocht u het vanavond tijdens het zappen zo heerlijk rustig vinden op televisie: graag gedaan!)
Uiteraard moet hij lekker zelf weten met wie hij wel en niet praat. Met zijn filmpjes over videogames en zijn eigen leven heeft hij 1,39 miljoen abonnees bij elkaar gescharreld. Ergens wil je bij al zijn levenskeuzes je duim opsteken en verder gaan met je eigen leven. Koopt hij een Ferrari van drie ton? Mooi man, veel veilige kilometers. Slaat hij een nieuwe vriendin aan de haak die, net


Gio en zijn vriendin Lynn willen geen 'jammerende BN'ers' worden genoemd.




als zijn ex, over jouw rug bekend hoopt te worden? Och, ieder huisje heeft zijn kruisje.
Domme keuze
Maar ik ben een beetje bang dat dat bij dit soort figuren juist het probleem is dat ze alles kunnen doen waar ze zin in hebben. En dat mensen die zoveel volgers hebben vergaard door ‘zichzelf’ te zijn, op een gegeven moment nauwelijks nog bij te sturen zijn. Als dan iemand wat zegt van een domme keuze die je zelf hebt gemaakt, is de reflex om stampvoetend Snapchat aan te slingeren. En dan sta je ondanks je prachtige sportauto toch gewoon enorm voor paal.
ChatGPT
Want laten we wel wezen: hij hóéfde niet naar Dubai. Zelfs de voetballers die in Qatar moesten spelen, begrepen dat er over zaken als mensenrechten niet onderhandeld mag worden. Zijn vriendin Lynn wist het nieuws te halen doordat ze aan ChatGPT gevraagd bleek te hebben of het oorlog was en het antwoord (‘nee’) serieus nam, maar het
was te moeilijk om vóór het boeken van de vlucht even aan diezelfde chatbot te vragen of er nou een beetje goed gezorgd is voor de Nepalezen die hun ongetwijfeld peperdure hotel gebouwd hebben.
Eigenlijk alles dat je over Gio moet weten, is het feit dat hij in 2024 een peperdure villa voor zijn gezinnetje kocht in Sint Willebrord.
Gio investeerde doodleuk €2,3 miljoen in het Brabantse dorp uit de gelijknamige Videolandserie, maar wil nu alweer van dat huis af omdat Sint-Willebrord ‘niet de juiste plek’ is voor zijn gezin. Dan is het ineens ook niet zo gek dat hij voor zijn vakantie midden in de oorlog tussen de VS en Iran belandde, wat welbeschouwd ook niet zo’n heel geschikte plek is voor een jong gezin. ■






IT’S IT’S IT’S A SOFT, JUICY,





EMILE BODE
Klustips & tricks
cks bode





April is een maand waarin de tuin weer wakker wordt. Niet dat alles er meteen prachtig bijstaat, want de groei moet nog echt beginnen, maar je merkt aan alles dat Nederland ontwaakt en de tuin zich klaarmaakt voor een nieuw seizoen waarin straks alles groeit en bloeit. Vanaf begin april kun je eenjarige zomerplantjes kopen.

Vorig jaar, begin april, ging het ineens los. Nog vóórdat de winkel om 9 uur open ging, stond er al een file met mensen die precies hetzelfde kwamen doen: zomerplantjes inslaan. Uw columnist was ook van de partij. Omdat wij een grote tuin hebben, kocht ik zo’n vijfhonderd plantjes voor in de
Snel en uitbundig
Eenjarige perkplanten groeien snel en uitbundig. Ze komen


potten. Het jaar daarvoor waren het er duizend. U denkt: die man is niet goed wijs. Dat klopt, maar voor vijfhonderd plantjes was ik nog geen €60 kwijt. Dat betaal je ook voor een beetje struik.

Eenjarige perkplanten groeien snel en uitbundig.
meestal na een jaar niet meer terug door de vorst. Ik laat geraniums en fuchsia’s in de schuur overwinteren, want dan overleven ze de winter wél. Koop het liefst een grote pot. Onderin maak ik twee gaten en vul ik een oud pantykousje met zogeheten hydrokorrels, die ik dichtknoop. Dat leg ik onder in de pot voor een
goede afwatering. Daarna gaat er tuinaarde in, met bovenop de laatste 15 centimeter potgrond.
Zet de planten bij nachtvorst binnen.

Poot de plantjes vrijwel tegen elkaar aan, dat is het mooist. Zet ze in de zon of halfzon en geef bijna elke dag water, bij zeer warm weer zelfs meerdere keren per dag. Richt het water niet op de bloemen, maar in de pot, zodat het ook de wortels bereikt. Verwijder uitgebloeide bloemen, dan maken ze snel weer nieuwe knoppen. Als er nachtvorst op komst is, zet de potten in een vorstvrije ruimte. De petunia is mijn favoriet; die kan tot de vorst blijven bloeien. Dat geldt ook voor de onverslijtbare begonia, die het ook in halfschaduw goed doet.
Ook het vlijtig liesje mag niet ontbreken. Die zet ik ook in de volle grond. Verbena is tevens een must. De meest verkochte perkplant is nog steeds de oersterke geranium. Ik zet die meestal onder een afdakje. Lobelia mag ook niet ontbreken, een ideale hanger. Ook veel verkocht zijn de afrikaantjes. Ik vind ze niks, maar over smaak valt niet te twisten. Combineer de perkplantjes in de pot.

De familie Van der Spek heeft de leukste tuinwinkel van het land.


Ruim vijftig jaar geleden begonnen Teun en zijn vrouw Alie van der Spek in Zevenhuizen, met de verkoop van appels en peren uit eigen boomgaard. Het dorp sprak al snel over ‘het Appelboertje’.
Daarna volgde uitbreiding op uitbreiding: een verswinkel, bloemen en uiteindelijk een tuincentrum. Dat groeide en groeide. Twee jaar geleden werd het tuincentrum volledig vernieuwd en heropend. Op het terrein zijn ook de verswinkel Spekvers, een restaurant, een speeltuin en een kinderboerderij. „Bij ons ben je een dagje uit, want ook de kinderen hoeven zich niet te vervelen”, zegt Matthijs Konijn, verantwoordelijk voor marketing. Bij Van der Spek werken
inmiddels zo’n 160 mensen, fulltime en parttime. Vader Teun is opgevolgd door zoon Martien, die het familiebedrijf nu samen met zoon Ton runt. Teun kijkt nog op afstand mee. Het tuincentrum valt vaak in de prijzen. In 2025 werd het tijdens een publieksstemming van InRetail uitgeroepen tot leukste winkel van Nederland, in de categorie tuincentra.
Matthijs zegt: „Wij zijn een christelijk bedrijf en op zondag gesloten, en we blinken ook niet uit in kerstartikelen. Maar ach, vijfhonderd meter verder zit een vestiging van Intratuin.”
Van der Spek. Bredeweg 110, Zevenhuizen spekvoordeel.nl




Duo Penotti ondersteunt duurzamere landbouw door het inkopen van cacao van Rainforest Alliance gecertifi ceerde boerderijen.








Ik krijg af en toe ‘wenkbrauwen-fronstips’. Zo had een lezeres last van aambeien. Niets hielp. Ze kocht laurierdrop en sindsdien heeft ze nooit meer last. De drop zou ook antiseptisch op de luchtwegen werken en helpen bij griep, tandpijn en aften. Andere mensen smeren de aambei in met tandpasta, waarna die zou uitdrogen. Zelf zou ik toch even advies vragen aan de huisarts.


De vraag komt regelmatig langs: hoe kan ik een vervuilde grafsteen schoonmaken? Vaak is de steen aangetast door weersinvloeden zoals algen en vallend blad. Het probleem doet zich vooral voor bij oude, grove en vaak geciseleerde grafstenen. Een beproefd middel om vervuilde grafstenen schoon te maken is steenzeep. Steenzeep kunt u het beste kopen bij winkels die grafzerken verkopen. Een bekend merk is het Belgische Akemi. Vloeibaar te koop voor ongeveer €15 op internet.











Een lezer vertelde mij dat hij de lades van zijn versleten en overbodige diepvriezer in de schuur heeft bewaard. Hij gebruikt de eerste lade als wasmand, de tweede voor poetsdoeken en dweilen en de derde voor lege flessen en potten voor de glasbak.

Steeds minder mensen dragen een pak. Ik ben bij condoleances wel eens jonge mannen in korte broek tegengekomen. Ik heb de hele wereld mogen bereizen en ben tot de conclusie gekomen dat Nederlanders een van de slechtst geklede volkeren op aarde zijn. Uitzonderingen daargelaten. Zoals mijn vrouw, kinderen en kleinkinderen. Zij lopen er altijd piekfijn bij en voor belangrijke gelegenheden word ik bij wijze van spreken door de familie aangekleed. Mijn vrouw hangt heel vaak kleding buiten om te luchten. Helpt dat, want dit zie je steeds minder als je door een woonwijk loopt? Het helpt zeker, want tegenwoordig wordt een herenpak slecht onderhouden. Hoe deed men dat vroeger?
Op een frisse en zonnige dag werd het pak buiten gelucht. Onaangename geuren verdwenen dan grotendeels. Daarna werd het pak grondig afgeborsteld en werden de zakken binnenstebuiten gekeerd en uitgeklopt. Heel vuile zakken werden gereinigd met een sopje van huishoudzeep en met een warm strijkijzer droog gestreken. De voering en de vette kraag werden voorzichtig afgenomen met een vochtig doekje met ammoniak en net zo lang gewreven tot de ammoniak was verdampt. Het strijken en oppersen was zeer precies werk. De broek werd eerst aan de binnenkant gladgestreken. Daarna jasje en vest, zomen en naden. Geen wonder dat veel mannen nu denken: ik doe wel een trui aan Die hoef je alleen maar buiten te hangen om te luchten.



















































































Vergeet dat tuinplan. Je staat toch weer te twijfelen boven een leeg stukje border en voor je het weet heb je potten gekocht die nergens lekker passen. Beter is om eerst te gaan kijken, buiten, in het echt. Maak van je wandeling een missie en loop langs voortuinen, door een park, over een dijk of langs een begraafplaats, plekken waar planten het al jaren moeten doen met wind, grond en droge weken. Kijk naar wat er rustig bij staat op lastige plekken. Onder struiken in halfschaduw, langs een schutting met weinig zon, in een hoek waar het na regen lang nat blijft. Als iets daar nog steeds goed oogt, kun jij er thuis bijna altijd iets mee. Maak een paar foto’s van het hele vak, niet alleen een bloem van dichtbij, en zet er meteen één korte zin bij in je notities, anders blijft het bij ‘mooi’. Thuis pas je dat idee aan op jouw tuin. Zo voorkom je impulsaankopen waar je later nog een plek voor moet verzinnen.

stinzentuin is een tuin met verwilderende voorjaarsbloeiers die ooit rond Friese ‘stinzen’ (middeleeuwse torens), landhuizen en buitenplaatsen zijn aangeplant, en daar zijn blijven terugkomen. Het zijn niet alleen bollen, maar ook knollen en wortelstokken. Je plant ze in het najaar in groepjes, liefst in halfschaduw onder bladverliezende bomen of langs een haag, in grond die in het voorjaar licht vochtig blijft. Daarna laat je het loof gewoon afsterven, dat is precies waardoor ze het jaar erop weer terugkomen. Na een paar seizoenen krijg je vanzelf slingers en vlekken in





plaats van losse stippen. Denk aan sneeuwklokjes, sneeuwroem, holwortel, wilde narcis, kievitsbloem en (bos) hyacint. Zodra het wat warmer wordt, kan het beeld per week veranderen.
1
ZOMERBOLLENTIJD

Zet zomerbollen de grond in, RIL


Zet zomerbollen in, gladiolen, lelies, crocosmia. t



2

Oude tak eruit, rest licht terugsnoeien, voeding erbij. j.

3







Check na zachte nachten, vooral bij jonge scheuten.











De kievitsbloem valt in april meteen op, juist omdat hij zo bescheiden blijft. Aan een dunne steel hangt een klokje met ruitjes, alsof iemand er met de hand een schaakbord op tekende. Officieel heet hij Fritillaria meleagris. In Overijssel hoor je ook vaak de bijnaam ‘Zwolse tulp’.
Hij oogt zeldzaam en een lijkt misschien tikje moeilijk, maar in de tuin valt dat erg mee. Het draait vooral om de plek. Kies grond die in het voorjaar niet meteen uitdroogt en waar het na een bui niet als een plasje blijft staan. Een lage hoek in de border werkt vaak beter dan een droge zandplek in volle zon.
Natuurlijk effect

bollen in het najaar, september of oktober is ideaal. Laat ze niet weken op de vensterbank liggen, want ze drogen snel uit. Tien tot vijftien centimeter diep is prima. En zet ze liever niet als één los exemplaar neer, maar als groepje. Met vijftien bij elkaar krijg je meteen dat natuurlijke effect. Na de bloei ziet het er even minder strak uit, maar dat hoort erbij.
Na een paar jaar krijgt de kievitsbloem die gewenste verwilderde look
Bij een vijverrand kan ook, of een stuk tuin waar regenwater naartoe zakt. Een handje bladcompost of wat humus helpt, omdat de bodem er luchtiger van wordt en langer vochtig blijft. Plant de
Laat het loof gewoon met rust tot het geel wordt en inzakt. Dat blad voedt de bol voor volgend jaar. Een dun laagje compost in het voorjaar is genoeg, zware mest hoeft niet. Reken ook niet op vuurwerk in het eerste jaar.
Voorjaarsgezelschap
Soms zie je een paar seizoenen vooral blad en pas later bloemen. Maar als hij eenmaal op gang is, komt hij trouw terug en kan hij zich ook langzaam uitbreiden.


Dan krijg je na een paar jaar ineens die fijne verwilderde look waar mensen altijd naar op zoek zijn. Qua buren houdt hij van hetzelfde soort voorjaarsgezelschap. Wat bosanemoon eromheen geeft licht en lucht. Longkruid zet er wat blad en kleur naast en speenkruid vult de bodem met geel. ■

De Zwolse tulp is ook een hommelplant. In april zijn koninginnenhommelnet wakker en gaan ze meteen op zoek naar nectar. kievitsbloemenBij moeten ze echt even aan het werk, maar ze kunnen erbij.

























Eerst iets hartigs, daarna iets fris. Een stevige andijviestamppot met krokante schouderkarbonade voor een volle, warme maaltijd. Als afsluiter, een luchtige aardbeienkwarktaart met een knapperige bodem. Twee gerechten die elkaar mooi aanvullen en waar iedereen aan tafel blij van wordt.

‘Stamppot
beter wordt het niet’




✔ 1 kg kruimige aardappels

Voor de karbonades


✔ 1 krop andijvie, ongeveer 500 g, fijngesneden
✔ 200 g gerookte spekjes
✔ 100 g crème fraîche
✔ 150 ml melk
✔ Peper en zout
✔ 4 schouderkarbonades
✔ 1 tl kerriepoeder
✔ 1 tl knoflookpoeder
✔ Zout en peper
✔ 100 g roomboter

Voor de bodem

Bereiding voor vier personen
• Schil de aardappels, snijd ze in gelijke stukken en kook ze in ongeveer 20 minuten gaar in water met een snuf zout.
• Bak ondertussen de spekjes in een droge koekenpan krokant en laat ze eventueel uitlekken op keukenpapier.
• Giet de aardappels af en laat ze kort droogstomen. Voeg melk en crème fraîche toe en stamp tot een smeuïge puree. Roer de rauwe andijvie en de spekjes door de puree.
• Breng op smaak met peper en eventueel extra zout.
Voor de karbonades
• Haal het vlees 20 minuten van tevoren uit de koelkast. Dep de karbonades droog en kruid ze royaal met peper, zout, kerrie- en knoflookpoeder.
• Verhit de boter in een koekenpan. Bak de karbonades op middelhoog vuur ongeveer 5 minuten per kant goudbruin en gaar.
• Laat ze na het bakken 5 minuten rusten onder aluminiumfolie.

✔ 400 g aardbeien

✔ 200 g speculooskoekjes, en wat extra voor garnering
✔ 125 g ongezouten roomboter
Voor de vulling
✔ 12 blaadjes witte gelatine
✔ Sap van 1 perssinaasappel
✔ Rasp van 1 citroen
✔ 500 g magere kwark
✔ 200 g witte basterdsuiker
✔ 250 ml verse slagroom


Bereiding 8 tot 10 punten
• Verkruimel de speculooskoekjes fijn, in een keukenmachine of in een zak met een deegroller. Smelt de roomboter en meng met de koekkruimels. Bekleed de bodem van een springvorm van ongeveer 24 cm met bakpapier. Druk het koekmengsel stevig op de bodem en zet minimaal 30 minuten in de koelkast om op te stijven.
• Week de gelatine 10 minuten in koud water. Pureer 300 g van de aardbeien en bewaar 100 gram voor de decoratie. Verwarm de sinaasappelsap licht, maar laat het niet koken. Knijp de gelatine uit en los op in het warme sap.
• Meng de aardbeienpuree met de kwark, suiker en citroenrasp. Voeg het sinaasappelgelatinemengsel toe en roer goed door. Klop de slagroom stijf en spatel voorzichtig door het kwarkmengsel. Giet de vulling over de koude bodem. Zet de taart minimaal 4 uur in de koelkast om op te stijven, liefst een hele nacht.
• Snijd de overgebleven aardbeien doormidden en verdeel ze over de taart. Garneer eventueel met extra verkruimelde speculoos.











Vul een wijn- of ginglas met een paar blokjes ijs
Schenk
Prosecco en Sperone

Aperitivo erbij (50/50)


Voeg een scheutje bruiswater of frisdrank (lemon) toe Garneer het glas sierlijk met een schijfje sinaasappel




Het voorjaar proef je in je glas met de trendy cocktails op basis van wijn. Het zijn frisse drankjes waarbij wijn wordt aangevuld met extra smaakmakers zoals fruit. Ze zijn populair als lichter alternatief voor bier of sterke drank. Je drinkt ze heerlijk koel, met ijs in het glas en vers fruit als garnering. Ook zijn ze geliefd omdat ze minder alcohol bevatten.
De wijn vervangt bijvoorbeeld gin en vormt het uitgangspunt van de cocktail.
Daarnaast kun je mixen met bruiswater, vruchtensap, siroop of kruiden voor een frisse, fruitige smaak. Denk aan klassieke drankjes zoals sangria, maar ook aan modernere varianten als spritz of Tinto de Verano. Je kunt ze zelf maken of kiezen voor een kant-en-klare variant. Handig als er onverwacht bezoek voor de deur staat en je snel iets lekkers wilt serveren.

Heb je citroen in huis en een fles prosecco koud staan, dan ben je er al bijna. Even inschenken, roeren en je hebt iets dat net wat feestelijker voelt dan een glas wijn.
1
Vul een groot wijnglas royaal met ijsblokjes.

2
Schenk 30 ml Pallini Limoncello over het ijs.
3
4

Voeg 60 ml droge prosecco toe.

be sn




Een heerlijk fruitige, zoete bubbel met prettige aroma’s van perzik, aardbei of een combinatie van citroen en limoen. Licht van smaak en gemakkelijk drinkbaar. Ideaal als je zin hebt in iets zachts en net wat zoeter in je glas.
LEKKER BIJ: Een frisse salade, in een fruitsorbet of bij de borrel.
Een levendige Spaanse mousserende wijn van de macabeodruif met een alcoholpercentage van 8,5 procent. Deze bubbel is droog en fris van smaak en door het neutrale karakter geschikt om te mixen of om zo te drinken, bijvoorbeeld bij een dessert.
LEKKER BIJ: Voorgerechten, desserts en als aperitief. Ook geschikt om te mixen.






6
Schenk 30 ml bruiswater erbij.

5
Roer voorzichtig zodat alles goed mengt.
Garneer met een schijfje citroen, een takje munt of sinaasappelpartje.









Wijncocktails zijn geliefd om hun frisse, toegankelijke karakter. De balans tussen zoet en fris kun je eenvoudig zelf bijsturen. Houd je van iets droger, kies dan voor een extra brut prosecco of voeg wat extra bruiswater toe. Mag het juist iets voller en zoeter, verhoog dan de verhouding limoncello licht. Begin met ijs in het glas en proef voordat je extra siroop of likeur toevoegt. Een kneep verse citroen of wat extra bruiswater maakt het glas vaak frisser zonder dat het zwaarder wordt.






Martine: ‘Je ruikt de tomaten al als je bij
„Ruik je dat?” zegt Martine Hermans (65). „Die tomaten, die meloenen...” Ze lacht.
„Alles ziet er zó goed uit dat je moet oppassen dat je niet te veel koopt. Want met die prijzen wordt het al snel verleidelijk.”
Martine Hermans doet haar boodschappen het liefst één keer per week. „Dan weet ik precies wat ik nodig heb. Thuis kijk ik wat er nog in de kast staat, koffie, thee, dat soort dingen. Daarna kijk ik hier naar de groenten en neem ik vaak de aanbiedingen mee.” Dat vindt Martine prettig aan Dirk. „Ik heb geen zin om meerdere winkels af te lopen. Hier haal ik alles in één keer.”
Tijdens het praten stuurt ze haar winkelwagen naar het actieschap. „Hier ga ik altijd langs.” Ze wijst naar een krukje in de vorm van een olifant. „Hoe leuk is dit?” Nog geen minuut later ligt het krukje in haar winkelwagen. „Dat bedoel ik dus. Je vindt bij Dirk altijd wel iets onverwachts. Voor die prijs laat je dat toch niet staan.”
Wat Martine prettig vindt, is dat de prijzen duidelijk zijn. „Bonuskaartjes, pasjes of apps vergeet ik altijd; die heb ik bij Dirk niet nodig. De prijs is gewoon de prijs. Dat vind ik eerlijk.” Terwijl ze verder loopt, groet ze iemand bij de kassa. „Het personeel is vriendelijk en je komt nog wel eens iemand tegen voor een praatje.”
Vanavond kookt Martine voor vier vrienden: „Moussaka, kip uit de oven, tzatziki en een salade. En daarbij gevulde aubergine met tomatensaus.” Sommige dingen maakt ze zelf, andere koopt ze. „Dolmades uit een blikje, die wijnbladeren is te veel werk om zelf te maken.”
Net een kraai
Pasen viert ze altijd uitgebreid. „Mijn kinderen zijn Grieks en daar is Pasen een van de belangrijkste feestdagen van het jaar. Dan eten we samen. Natuurlijk heb ik dan ook gekleurde paaseitjes. Alle kleuren door elkaar. Ik ben net een kraai.” Bij de kassa kijkt ze nog even in haar winkelwagen, en naar de olifant voorin. Lachend: „Zie je, je komt voor boodschappen en je gaat naar huis met een olifant.” ■






















Zure haring van Ouwehand is fris, vertrouwd en altijd lekker. Op een broodje, bij de borrel of gewoon tussendoor.






wihr se n

Wie hier aankomt met een hoofd vol lavendel en rosé, moet even schakelen. In de Vogezen ruikt het naar nat hout. Naar mos. Je rijdt door bossen en denkt dat er niets komt. Tot er ineens pittoreske dorpjes opdoemen als Riquewihr en Kaysersberg met hun Duitse architectuur. En wat te denken van het middeleeuwse Château du Haut-

DKoeni sbourg?









Logeren in een oude L’Anciennehoutzagerij,Scierie.



Château du HautKoenigsbourg: 757 meter hoog, uitzicht tot het Zwarte Woud.











e Vogezen zijn nooit gewoon Frankrijk geweest. Eeuwenlang schoof hier een grens heen en weer. Dat voel je nog steeds. De Route des Crêtes volgt de bergkam en tekent die oude scheidslijn. Aan de westkant liggen bossen, boerenerven en oude houtzagerijen. Rijd je de kam over naar de Elzas, dan verandert het beeld. Typisch 'Duitse' huizen. Uithangborden in het Duits. Straatjes ogen net iets strakker. Je hebt nog geen half uur
gereden en toch voelt het alsof je een ander land bent binnengereden.
L’Ancienne Scierie
Onze uitvalsbasis is Bois de Champ, een gehucht langs de N420 tussen Épinal en Saint-Dié-des-Vosges. Op papier 425 meter hoog, maar vooral diep in het bos. We slapen in L’Ancienne Scierie, een sfeervolle negentiende-eeuwse houtzagerij waar letterlijk een beek onder het gebouw door stroomt. ’s Avonds hoor je het water onder het terras. Albert en Laetitia Veenstra kopen het pand in 2005. Na een brand bouwen ze alles opnieuw op. Hun zoon Bart helpt mee en hond Max loopt mee het bos in alsof hij er werkt. Voor boodschappen rijd je tien minuten naar Bruyères.
Vakwerkhuizen
De volgende ochtend gaan we weer op pad. Donkere sparren, wat mist tussen de velden, boerderijen langs de weg. En dan, na een paar
bochten, verandert alles. Hier begint de Elzas. Riquewihr, Kaysersberg, Ribeauvillé. Vakwerkhuizen staan schouder aan schouder, straatjes van kasseien, bloembakken die over de vensterbanken hangen. Stadsmuren staan er nog gewoon. In een bakkerij hangt een krijtbord met dagaanbiedingen in twee talen. De vrouw achter de toonbank groet ons in het Frans en schakelt halverwege de zin over op Duits. Niemand kijkt ervan op.
Château du HautKoenigsbourg
Boven die dorpen, op een smalle bergkam, ligt Château du HautKoenigsbourg. Op 757 meter hoogte kijk je uit over de Elzasvlakte en, bij helder weer, tot aan het Zwarte Woud. Binnen lopen we door ridderzalen en keukens met metersdikke muren. Buiten, op






de kantelen, snap je meteen waarom deze plek ooit gekozen wordt. Vanaf hier werden de handelsroutes haarscherp in de gaten gehouden; ze zagen alles aankomen.
Tussen de dorpen slingert de Route des Vins d’Alsace. Wij stappen een kelder binnen waar weinig wordt uitgelegd en veel wordt ingeschonken. Een droge riesling, strak en fris. Daarna een gewürztraminer die inderdaad naar lychee ruikt, maar ook iets kruidigs heeft. Na de wijn weer de bergen in. De Route des Crêtes dwingt je om te stoppen. Om de paar kilometer sta je toch weer langs de kant voor een uitzichtpunt. Bij La Bresse gaan









De ooievaar, geluksbrenger van de Elzas.












Vanuit het chateau werden de handelsroutes haarscherp in de gaten gehouden





































































































































we op de zomerrodelbaan naar beneden en sluiten af met een tarte flambée met room, ui en spek in een simpel bergrestaurant. In de winter is dit een heerlijk skigebied met langlaufers en sleepliften. In de zomer verdwijnen mountainbikers met downhillfietsen in de stoeltjes-lift om even later weer naar beneden te knallen.
Rotsen en kloven
De dag daarop gaan we de Sentier des Roches op. Geen wandelpad voor slenteraars, maar een route langs rotsen en kloven waar je soms echt moet kijken waar je je voeten neerzet. Het weer doet hier wat het wil. Mist trekt op, de zon breekt ineens door en het uitzicht verandert in minuten. Even verderop ligt Lac de Gérardmer,







het grootste meer van de Vogezen. Op warme dagen liggen mensen met hun handdoek aan de oever. In de winter ligt het stil tussen kale bomen en sneeuw.
Sorbetkleuren
We rijden de bergen weer uit en belanden in Colmar. Smalle straatjes met vakwerkhuizen in sorbetkleuren, houten balken die scheef lijken te staan maar al eeuwen blijven zitten. In Petite Venise glijden bootjes onder lage
In de winter is dit een heerlijk skigebied met langlaufers en sleepliften



bruggen door en spiegelen de gevels in het water. Colmar is groter dan Riquewihr, maar heeft ook absoluut charme. Overal bloembakken, uithangborden van smeedijzer, etalages vol handgemaakte keramiek en vintage vondsten. En dan is er die kerstsfeer die hier nooit helemaal verdwijnt. Zelfs buiten december hangen er lichtslingers, houten kraampjes en etalages die zo uit een kerstfilm lijken te komen.
Uitzicht over de Rijn








Colmar: bloemenvakwerk, en Elzas-charme.




















De geschiedenis is hier nooit ver weg. Boven op de Route des Crêtes ligt Le Linge. We staan daar met uitzicht over de Rijnvallei en lezen op een kaart waar het front liep in de Eerste Wereldoorlog. Even verderop liggen nog loopgraven. Ook bij Hartmannswillerkopf zie je hoe hard hier is gevochten. Misschien is dat precies waarom het fijn is om ’s avonds terug te keren naar ons knusse logeeradres, L’Ancienne Scierie. Hout op de barbecue, een fles wijn open, brood en salade op tafel. Het riviertje onder het huis kabbelt gewoon door. Schoenen uit. Glas in de hand. Je denkt dat je nog iets moet. Maar eigenlijk hoeft er helemaal niets meer. ■
J ei enlij ets










Hartmannswillerkopf, was ooit de frontlinie.








































































Villa Glan ligt in Fontein, Banda Abou, helemaal in het westen van Curaçao. Linsey begon in 2022 met een dichtgegroeide kavel. Twee jaar later stond er een vakantiehuis met porch, privézwembad en een vrij uitzicht.
Joost:
„Erg mooie villa, die van alle gemakken is voorzien. Door de hoge ligging heb je prachtig uitzicht en zit je heerlijk in de wind. Bijkomend voordeel: we hadden nagenoeg geen last van muggen.”
„Wat in 2022 begon als een kavel vol struiken, ging na heel wat avonden met grote vellen papier aan de keukentafel over in een een zandbak met uitgezette vakken.” Linsey vervolgt: „Lijnen in het zand, onze ideeën op papier, en eindeloos dromen over hoe het moest worden. Stap voor stap, met veel geduld, keuzes maken, bijsturen en soms opnieuw beginnen, groeide het uit tot ons vakantiehuis op de Antillen.”
Beste van twee werelden Linsey en haar partner zochten ondertussen alles bij elkaar: van vloeren en meubels tot de keuken en zelfs de koffiebekers. Soms op Curaçao, soms
in Nederland, tot alle losse keuzes ineens één geheel vormden. „En toen viel het op z’n plek. Van schets tot zonsondergang. In 2024 stond daar onze Villa Glan.” Het beste van twee werelden komt hier samen: je zit zo bij stranden en beachclubs, maar bij de villa is het vooral rustig. „Binnen en buiten lopen moeiteloos in elkaar over”, zegt Linsey. „Vanaf de ruime porch en het privézwembad kijk je uit over een panoramisch landschap, met elke dag weer een zonsondergang voelt als een schilderij.”
Vanaf het moment dat de villa klaar was, besloten ze ’m ook te verhuren. Linsey: „Het idee dat mensen hier hun dierbare vakantieherinneringen maken, vinden we echt te gek. Voor ons heeft Curaçao alles: een ontspannen levensstijl, een aangenaam klimaat, prachtige stranden en die fijne balans tussen ontdekken en echt tot rust komen. Het eiland voelt vertrouwd, en is toch elke keer weer bijzonder.” ■


GESCHIKT VOOR 1-8 personen
BOEKEN
Geen boekingskosten en direct contact met Linsey.
BEOORDELING 8,8
MEER INFO? Scan de QR-code

OOK JOUW VAKANTIEHUIS VERHUREN? Begin met verhuren en ontwerp vrijblijvend je advertentie op Micazu.nl
JESSIE BALTUS


De meivakantie staat voor de deur en hieronder kun je alvast inspiratie opdoen om de dagen te vullen. Fijne lente!
Foam presenteert War is Personal, een solotentoonstelling van de Oekraïense fotojournalist en documentairemaker Julia Kochetova. Vanuit haar persoonlijke ervaringen brengt Kochetova de bezoeker dicht op het leven aan de frontlinies, waar zij de kwetsbare grens onderzoekt tussen documenteren, rouwen en overleven.

Gerson Main toert tot 5 juni door het land met de ontroerende theatervoorstelling ‘Weg van dit feestje’. In deze liefdevolle en ontroerende voorstelling neemt theatermaker en muzikant Gerson Main het publiek mee naar de foyer van een verzorgingshuis. Een plek die hij omschrijft als ‘het gezicht van zijn angst om ouder te worden’. In een muzikale dialoog vol krachtige liederen en poëtische teksten verkent Main thema’s als ouder worden, dromen, spijt en afscheid.


In het Van Gogh Museum is de tentoonstelling ‘Geel’ te zien. Meer dan Van Goghs lievelingskleur. Geel kan verwarmend, uitbundig en stralend zijn. Geel is ook gedurfd, opdringerig, soms ziekelijk. De tentoonstelling biedt een originele ervaring van deze krachtige kleur –in kunstwerken van Vincent van Gogh en tijdgenoten, aangevuld met muziek, literatuur en mode.

‘House of Banksy - An Unauthorized Exhibition’ laat zien waarom Banksy al jaren geliefd en geroemd is. Op ruim 1.500 vierkante meter in Las Palmas Rotterdam duiken bezoekers in Banksy’s wereld. De expositie belicht de scherpe tegenstellingen die Banksy’s werk zo iconisch maken, zoals humor en woede, hoop en cynisme, schoonheid en scherpte.

VLOED is het nieuwe jaarlijkse festival om het begin van de zomer te vieren. Geniet tijdens het Hemelvaartweekend drie dagen lang op binnen- en buitenlocaties van kunst, muziek, theater en dans. Een van de topacts op het festival is Neo-fanfare 9x13 met de première van de voorstelling Parade, die vervolgens langs de zomerfestivals toert. Van 14 tot en met 16 mei in Zandvoort.


BBC Earth’s Wild Asia: Life at Extremes draait vanaf 2 april in de Dome van Museon-Omniversum, het grootste koepelscherm van de Benelux. Ontdek nooit eerder gefilmde dieren in adembenemende landschappen in deze meeslepende grootbeeldfilm voor alle leeftijden. Tijdens de paasdagen en in de meivakantie worden er ook diverse activiteiten voor jong en ouder georganiseerd!








1
AVONTURENBOERDERIJ MOLENWAARD , GROOT-AMMERS (ZH)
Shows, attracties en dieren; educatief pretparkplezier voor jonge gezinnen.
2
SPEELBOERDERIJ DE HOOIBERG, BLADEL (NB)
Grote binnen- en buitenspeeltuin; ideaal bij wisselvallig voorjaarsweer.
3
SPEELBOERDERIJ BINKY, APELDOORN (GE)
Dieren, waterfietsen en ruime speeltuinen; klassiek en veelzijdig dagje uit.
4
SPEELBOERDERIJ DE HAPPYFARM, TERSCHUUR (GE)
Overzichtelijke speelboerderij met ponyritjes en indoor speelmogelijkheden.
5
GEERTJES HOEVE , HAARZUILENS (UT)
Geiten knuffelen, spelen in het weiland en ambachtelijk ijs proeven.
Wil je ook met een evenement in deze rubriek? Stuur een e-mail naar jessie@trustedmedia.nl

Ze zeggen dat wijsheid met de jaren komt. Ik weet inmiddels wel beter. De meest rake observaties en associaties horen we net zo vaak uit de monden van onze jonge bezoekers. De Australische dichter Erin Hanson (1995) was nog maar achttien jaar toen ze dit gedicht schreef. Je kent het vast van de laatste twee regels, die in 2014 viraal gingen:
There is freedom waiting for you, On the breezes of the sky, Andyouask‘Whatif Ifall?’ Ohbutmydarling,Whatif youfly?
De zinnen zijn inmiddels een vaste motiverende quote geworden die op menig poster prijkt. Erin Hanson schreef het gedicht vanuit haar onzekerheid over de toekomst en haar eigen schrijfwerk. Dat gevoel, iets heel graag willen, doodsbang zijn en toch moeten vertrouwen, is voor iedereen herkenbaar. Als je die woorden en dat gevoel zou vertalen naar een beeld, dan is dat voor mij het werk ‘Trust’ van kunstenaar Max Siedentopf (1991). Je beleeft het kunstwerk in het piepjonge museum Villa in Amsterdam.

Sietske van Zanten is directeur van het LAM, gewoon een bijzonder museum, midden in het groen van Landgoed Keukenhof in Lisse. Sietske presenteert regelmatig het televisieprogramma Nu te Zien! Volg het museum op Instagram via @lam_museum, of bezoek lammuseum.nl.
Jij laat je naar achteren vallen, iemand anders vangt je op. Je kent deze oefening in vertrouwen vast. Precies dat veilige gevoel krijg je in museum Villa. Dit museum, in een monumentale Ingenieurswoning, omringd door het groen van het Westerpark, voelt als thuiskomen bij een vriend. Een huiselijke sfeer, speelse kunstwerken en de perfecte hoeveelheid prikkels: hier ga je opgeladen weer naar buiten.



ku h h w



Van de stoppels tot de teennagels: het siliconen beeld van kunstenaar Max Siedentopf is echter dan echt. Alleen de houding is onmogelijk; alsof de man midden in zijn val is vastgevroren.
JE ZOU HAAST NAAR HET BEELD RENNEN OM DE MAN OP TE VANGEN. TOT JE ZIJN TEVREDEN GEZICHT ZIET. ALLES IS IN ORDE. DEZE MAN HEEFT VERTROUWEN.

Kunstkijken is ook altijd een beetje naar jezelf kijken. Voor bezoeker Chris die recentelijk in Museum Villa was, geldt dat letterlijk. Hij is een goede vriend van de kunstenaar en stond model voor het beeld.



In de museumzaal hangt nog een ander kunstwerk van Max Siedentopf. Een reclamebord vertelt je eerst dat je ertoe doet en niet moet opgeven. Daarna vertelt het je het omgekeerde. Precies: net dat stemmetje in je hoofd!

MAX SIEDENTOPF WERKTE VROEGER IN DE RECLAMEWERELD, EN DAT MERK JE: ZIJN KUNSTWERKEN PAKKEN JE BIJ DE KLADDEN, LATEN JE SCHRIKKEN EN LACHEN. JE KUNT ER ONMOGELIJK NÍÉT NAAR KIJKEN.
Om het kunstwerk zo te kunnen presenteren, moest de sokkel verzwaard worden met maar liefst 150 kilo zand.
10% KORTING



Met korting naar Villa
Zin om te vliegen met je ogen? Met de kortingscode DIRKVILLA10 krijg je 10% korting op je kaartje. www.museumvilla.com


Voor in je Nescafé®
Dolce Gusto® machine*

*Merken van een derde partij die niet verbonden is met JACOBS DOUWE EGBERTS.
Botan Takada eindigde vorig jaar als eerste bij Het Koninklijk Concertgebouw Concours. Nu de aanmelding voor het concours van 2026 van start is gegaan, roept de inmiddels dertienjarige celliste andere jonge talenten op om vooral mee te doen: „Het is een unieke ervaring en echt ontzettend leuk!”
1
Watgingerdoorjeheen toenjehetConcours gewonnenhad?
„Het moest echt even tot mij doordringen toen ik mijn naam hoorde noemen. Ik schrok een beetje, maar van blijdschap, hoor! Ik wilde graag aan het concours meedoen, vanwege de ervaring, en het is natuurlijk ook een heel erg mooi gebouw om op te treden. Maar dat ik zou winnen, had ik echt niet verwacht.”
2
Benjenerveusvoor eenoptreden?
„Niet echt. Ik vind het vooral heel erg leuk om voor mensen te mogen spelen. Bij de buiging haal ik nog eens diep adem en dan begin ik. Ik wil mijn cello aan iedereen laten horen, en dan hoor ik wel dat ze het leuk vinden. Ik ben vooraf niet echt nerveus, want ik weet dan dat ik een stuk ook echt beheers.”
Opwelkeleeftijdben jebegonnenmethet bespelenvaneeninstrument,enhoevaakoefenje?
3
„Ik was vier jaar toen ik een viool kreeg, maar een jaar later ben ik overgestapt naar de cello. Ik hou erg van de klank van de cello. Ik oefen dagelijks gemiddeld één
à anderhalf uur. Voorheen deed ik ook aan kaligrafie en aan modern dansen, maar daar ben ik mee gestopt, want het werd een beetje te veel allemaal.”
4
Komjeuiteen muzikaalgezin,en wieinspireertjou?
„Mijn vader is componist, mijn moeder geeft pianoles en mijn zusje speelt viool. Waar mijn inspiratie vandaan komt? De manier waarop Mischa Maisky cello speelt, vind ik heel grappig en interessant. Maar ik vind het werk van componist en cellist David Popper ook heel leuk.”
5
Wiljelatervanmuziek jeberoepmaken?
„Ja, dat wil ik zeker! Ik zit nu op het gymnasium en volg daarnaast een muziekopleiding aan het AKO.” (Het Atheneum

Kamerorkest van de School voor Jong Talent van het conservatorium Den Haag, red.)
6
Hebjeookietsmet moderne muziek?
„Ik luister de hele dag naar muziek, ook naar popmuziek. Maar ik speel het nooit op mijn cello. Het zou eigenlijk wel een leuke ervaring zijn om het een keertje te proberen. Ik ken ook best wel wat andere musici. Bij het Concours kwam ik ook mensen tegen die ik bij andere optredens al had leren kennen. Dat is altijd leuk, dan hebben we echt leuke gesprekken samen.”
Jeouderskomen uitJapan.Waarvind jehetleuker?In Japanof Nederland?
7
„Ik kom elk jaar in Japan, voor mij is het grootste verschil het eten. Ik vind Japans eten stiekem lekkerder dan Nederlands, of klinkt dat gemeen? Wat ook heel leuk was: vorig jaar had ik mijn eerste soloconcert in Japan, in de stad Yamagata. Dat concert in Japan, het Grachtenfestival in Amsterdam en het winnen van het Concertgebouw Concours waren echt hoogtepunten.” ■
JE AAN VOORDEZEUNIEKE ERVARING

Wil jij dit jaar meedoen?
Maak thuis een YouTube-video van een muziekstuk naar keuze van maximaal vijf minuten. Zet je filmpje op YouTube en stuur de link vóór 14 april naar concertgebouw.nl/educatie/koninklijkconcertgebouw-concours. De workshopdag is op 2 mei 2026, de halve finale op 31 mei, de masterclass op 14 juni en de finale op 21 juni.

























Ook hopeloze ervaringen met de sportschool?
Dan is het tijd voor Tai Chi. Met een vleugje
Oosterse invloed lijkt dit een geweldige kans op gezond leven. Doe ook mee met de nieuwe rage Tai Chi. Baat het niet dan schaadt het ook niet...

Je man is 57 jaar, hij weegt 130 kilo en zijn piepjonge sportschoolleraar van 26 zegt dat hij elke dag minimaal tienduizend stappen moet zetten. Wat doet de vijftiger fout?
Alles! Zegt de gespierde Tai Chi Walking -docent van Oosterse komaf. Je wilt minder stress, meer energie. Na drie dagen voelt je man zich beter, na zeven dagen zal zijn energieniveau
veranderd zijn en na een maand herken je je man niet meer.
KLIK OP DE LINK EN JE
KAN MORGEN BEGINNEN!
Een wasbord en minder kilo’s door zeven minuten per dag een paar oefeningen te doen? Wie wil dat niet?
Spring ook op de rage van Tai Chi Walking, want doe je als vijftiger niet mee dan ben je toch echt van lotje
getikt. Dát is de boodschap die de laatste maanden wordt uitgestort via sociale media. Laat de sportscholen links liggen, maar ga thuis zelf aan de slag met een hulpvaardige Kung Fu-master, een handige ‘bot’ die jou begeleidt naar een nieuw lichaam en je zelfs een nieuw leven bezorgt. Tai Chi Walking is het namelijk hélemaal: lage intensiteit, hoge beleving. Geen gehijg, geen spierpijn.

Maar een zoektocht naar een nieuw ‘balanssysteem’ en een zenuwstelsel dat moet gaan wennen aan rust, focus en stressreductie.





Tai chi walking draait om langzaam, bewust en gecontroleerd bewegen. In plaats van gewoon lopen verplaats je je gewicht heel geleidelijk van het ene been naar het andere. Elke stap begint met stabiliteit: je staat stevig, knieën licht gebogen, romp rechtop en ontspannen. Pas wanneer je gewicht volledig gedragen wordt door het standbeen, beweegt het andere been naar voren. Zo voorkom je schokkerige bewegingen en ontwikkel je balans. De beweging zelf is vloeiend en continu. Je zet de hiel zacht neer, rolt langzaam over de voet en voelt bewust hoe het gewicht zich verplaatst. Er is geen haast, de traagheid is juist de oefening. De armen bewegen ontspannen mee, zonder spanning, alsof ze zachtjes drijven. Ademhaling speelt hierbij een belangrijke rol: rustig, diep en gelijkmatig, zodat het lichaam ontspannen blijft.

genomen met een aanmelding bij een Tai Chi-cursus. Al heel snel krijg je een serie vragen voor je kiezen, of je die wilt beantwoorden en wat je doel is van de oefeningen. Ben je altijd ‘gezet’ geweest, wil je je buikje wegwerken of je schouderpartijen versterken? Quasi-nonchalant krijgen je vragen en nog eens heel veel vragen voorschotelt.

Tot zover het marketing-verhaal. We hebben de proef op de som

je vragen en vragen voo
W He ad trappen
Musc
r m’ en sel nnen en haal. We f d versterken? Q
Iedereen kan Tai Chi onder de kniekrijgen.
Heb je moeite met je ademhaling als je trappenloopt? De site Mad Muscles blijft eindeloos vragen stellen. Wanneer gaan we nou eindelijk eens beginnen?
vrag ga b ➜
Dan krijg je het signaal dat je persoonlijke plan van aanpak klaar is en of je even je emailadres wilt doorgeven. Daarna moet de kassa rinkelen, want het is wel de bedoeling dat je gaat betalen. Vanaf een halve euro per dag doe je al lekker mee. Tai Chi Walking vergt een specifieke techniek van lopen. Die kun je natuurlijk trainen. Maar hoe dan? De eerste keer is het behoorlijk lachwekkend. Je loopt extreem langzaam en bewust. Elke stap wordt gecontroleerd opgebouwd:







































Helemaal niet zweverig!
Lekker bewegen met Tai Chi.

eerst stabiliteit vinden, dan gewicht verplaatsen, dan pas de voet neerzetten. Je houdt je romp recht, ontspant de schouders en beweegt vloeiend zonder schokken. Het tempo dwingt je balanssysteem en kleine stabilisatiespieren continu te werken. Tegelijk zorgt de rustige ademhaling voor ontspanning van het zenuwstelsel.
Tot zover de theorie. De praktijk is weerbarstiger en dan komt het eerste bericht van ‘Master Lee’ als
geroepen. Deze Tai Chi coach maakt ook meteen duidelijk dat de prijs voor deelname geen obstakel hoeft te zijn, want in de mail wordt geschermd met een korting van maar liefst zeventig procent. Hoe aardig is dat? Goedkoper zijn de uitlegvideo’s op

YouTube. Je begint met een stap met je linkervoet. Je verplaatst je gewicht naar achteren en je voet maakt een beweging naar links en je trekt je rechtervoet bij. Een kind kan de was doen, zo lijkt het. Het leidt uiteindelijk tot een nogal ongemakkelijke manier van wandelen. Na een minuut of vijf ben je nauwelijks een paar meter opgeschoten.
In het Amsterdamse Oosterpark geeft de ervaren meester Chan al ruim veertig jaar Tai Chi-les in de buitenlucht. In het tv-programma Zin in Morgen gaf Chan een paar tips voor een succesvol Tai Chi-ochtendje. Laat je meevoeren door de wolken, het water en de wind, is het devies. Verder, zoek een rustig plekje, draag gemakkelijke kleding, neem de tijd, concentreer je op je ademhaling, heb geduld en wees niet bang voor spierpijn. Aan dat laatste schort het nogal bij de hippe Nederlandse Tai Chi-idolaten. Want ze blijken nogal snel af te haken als de spieren gaan muiten… Vooralsnog lijkt Tai Chi vooral trending bij de wat oudere mannen die van hun buikje af willen. ■
Leer om stappen naadloos in elkaar te laten overlopen, zonder pauzes of schokken. De beweging wordt een zachte, ononderbroken stroom waarbij het lichaam ontspannen blijft terwijl je balans dynamischer wordt. Daarnaast komt er meer focus op rotatie en lichaamsverbinding. Bij tai chi beweegt het lichaam als één geheel: heupen, romp en armen werken samen. Beginners oefenen subtiele draaiingen vanuit de heupen, waardoor stappen natuurlijker en lichter aanvoelen. De armen bewegen niet langer alleen mee, maar worden onderdeel van het evenwicht en ritme. Tot slot wordt de mentale component verdiept. De aandacht ligt niet alleen op de voeten, maar op het hele lichaam en de omgeving.


















ddels de vaste
Tina Nijkamp is inmiddels de vaste kijkcijferduider van Nederland en zit nu ook aan tafel bij
Nederland en en zegt




Inside. Ze kijkt, telt en zegt hardop wat tv-makers liever inslikken. Ze heeft niets met glitter en status. Met Hilversums ‘kijk mij eens’, inclusief Porsche-praat en gepamperde luxepaarden, al helemaal niet.
Ze er en status. Met t pamperde maal niet .











Tina is razendsnel uitgegroeid tot de ultieme tv-criticus. Eerst als kijkcijferduider die elke ochtend de scores fileert, daarna als mediacommentator die haarfijn uitlegt waarom een zender de plank misslaat. Bij Vandaag Inside promoveerde ze van barkruk naar vaste stoel, op een plek die jarenlang van Angela de Jong was. Mediaexpert Victor Vlam kijkt intussen mee met samengeknepen billen: hij is minstens zo 'hongerig' naar roem.






NAAM: Jantina ‘Tina’ Nijkamp
GEBOREN: 25 juni 1972, Bathmen, Overijssel
RELATIE: Tina is sinds 2000 getrouwd met televisiemaker Jasper van der Schalie. Samen hebben ze twee kinderen, een zoon en een dochter, allebei geadopteerd uit China.








STUDIE: Universiteit van Amsterdam, communicatiewetenschap. Studeert nu rechten.



Over de neppe tv-wereld: „Daarom wil ik ook nooit naar het Televizier-Ring Gala. Als ik daar binnenkom, dan is het: Hééé, hoooi! En dan draai je je rug om, en dan is het: Jézus, wat is dat ook een troela, hè, die Tina?”




Over haar jeugd: „Ik omschrijf het als een boerzoektvrouwgezin met een kleedje op tafel. Heel traditioneel, warm en liefdevol”










OVER THOMAS VAN GRONINGEN




OVER ANDRÉ HAZES

S
„Ik vind het echt een heel narcistische artiest”

„Je moet vaker bij je kind zijn” artiest





Tina groeide op op een boerderij in Bathmen.
„We hadden een gemengd boerenbedrijf, koeien en akkerbouw.”


OVER NIKKIE PLESSEN

„Ik vind haar gewoon zó hautain altijd. Elitair”


OVER HELGA VAN LEUR



„Ik heb haar áltijd al vreselijk gevonden. Zij was ook altijd heel jaloers op Piet Paulusma destijds”




















OVER GERT VERHULST

„Een nare dominante man, heeft dedain voor vrouwen”




Over haar nanny strategie: „Ik heb toen gevraagd aan het bureau van: kun je me de lelijkste uit het pakket sturen? Anders ligt straks de nanny in bed met m’n man!”





„Gordon heeft echt een pésthekel aan mij”

Als steunbetuiging
naar Linda de Mol:
„Ik zit ook vol met botox!”




„Ik durf niet in het donker over straat te lopen”



Vanaf dat ze acht was, wilde ze bij de tv werken. Ze vertrok naar Amsterdam. „Ik wist meteen: hiermoetikzijn.” Bij SBS werd ze op haar 32ste programmadirecteur.
Nieuwe vorm
Meisje kan wel uit het dorp gaan, maar het dorp gaat nooit uit het meisje (1977).
ht j k iermoet ik zijn ” SBSwerd




In 2011 stopte ze, omdat haar privéleven instortte. „In tweeënhalf jaar overleden mijn moeder, mijn zus en mijn vader. Allemaal aan kanker.” Het ging niet meer samen met de druk van die baan. „Mijn man heeft gebeld: Tina komt niet meer.” Ze werd huismoeder en genoot daarvan: ,,Wasjes draaien, er voor de kinderen zijn, met de hond naar buiten.” Later vond ze een nieuwe vorm, als televisiewatcher.




BRIDGET MAASLAND
„Oeh, we zijn allemaal bang voor Tina Nijkamp. Maar why? Het is één iemand z’n mening.”
GORDON
„Het interesseert me echt geen ene moer meer wat zij denkt, schrijft of doet. Ze moet alleen d’r smoel houden en geen onwaarheden vertellen.”



RENÉ
VAN DER GIJP

„Dat is een enorme lieverd. Echt een heel, heel aardige vrouw.”























































Milka Alpenmelkchocolade met Lotus Biscoff® biscuit crumble








Monique Smit viert deze maand haar 37ste verjaardag. En terwijl de breuk met broer Jan nog altijd als een wolk boven Volendam hangt, gaat zij stug door. In de Alpen, in Brabant, overal waar een podium staat.






Haar feestnummers verdwenen eind vorig jaar ineens van Spotify. Precies die songs waarmee Monique Smit normaal gesproken haar zalen (en zakken) vult, inclusief kerstliedjes. Officieel lag het onaangename besluit bij het label. Alleen: dat label wordt gerund door haar bloedeigen broer Jan. Hij stelt dat het haar eigen schuld is. Zij zou 'heel goed weten waarom'. Wat er precies is geëscaleerd tussen broer en zus, blijft onduidelijk. In Volendam wordt al langer gesproken over spanningen en stevige woordenwisselingen. Monique heeft een mening en ze schroomt niet die ook te verkondigen.
Selfies
Intussen doet de zangeres wat ze altijd doet: doorgaan. In Oostenrijk zong ze in Flachau, Westendorf, Kirchberg, Königsleiten en Gerlos. Tijdens carnaval was ze volop te vinden in het zuiden van het land. Het sprookje van de zingende broer en zus lijkt voorbij, maar Monique zet de vaart erin. Inmiddels ligt broer Jan in scheiding. ■






Wie zijn
Inmiddels ligt broer Jan in zijn eer

nog meer








NIENKE PLAS
Influencer en actrice 3 april, 40 jaar





















SYLVIE MEIS
Infuencer en actrice 13 april, 48 jaar

PAAY Zangeres 7 april, 77 jaar

NOORTJE HERLAAR Actrice 22 april, 41 jaar
RENÉ VAN DER GIJP VI-ster 4 april, 65 jaar




door Savanna Bosch

STIER 21 april - 21 mei
Je zoekt houvast, maar je merkt ook dat er iets nieuws aan je trekt. Dat hoeft elkaar overigens niet te bijten. Kleine veranderingen in huis of in je dagelijkse ritme geven meer energie dan je denkt. Op werk kom je verder met concrete stappen dan met grootse plannen. In relaties draait het om vertrouwen en heldere afspraken. Kijk ook eens kritisch naar je vaste lasten. Minder ballast zorgt voor meer rust in je hoofd, beste Stier.
TWEELINGEN 22 mei - 21 juni
RAM
21 maart - 20 april
Je staat lekker in de startblokken, maar je hoeft niet meteen vol gas te gaan. Je energie is hoog en je enthousiasme werkt aanstekelijk, al kan niet iedereen jouw tempo bijbenen. Kies op werk één duidelijke prioriteit en maak die af, in plaats van overal tegelijk aan te trekken. In de liefde win je meer met eerlijkheid dan met haast. Single Rammen kunnen zomaar verrast worden. En financieel geldt: eerst nadenken, dan pas pinnen.
SCHORPIOEN 24 oktober - 22 november
Je ziet scherp wat wel en niet werkt. Gebruik die scherpte zonder alles op scherp te zetten. Op werk kun je een oud probleem eindelijk oplossen. In relaties werkt eerlijkheid sterker dan controle. Financieel is het slim om oude afspraken te checken en waar nodig bij te stellen. Loslaten voelt spannend, maar geeft ruimte. Vertrouwen in jezelf maakt deze maand het verschil.

De agenda loopt snel vol en je hoofd nog sneller. Deze periode vraagt om focus. Kies bewust waar je ja tegen zegt. Op werk kun je indruk maken door een idee eindelijk concreet te maken in plaats van weer iets nieuws te starten. In relaties helpt het om écht te luisteren, dus niet alleen te reageren, Tweelingen. Financieel is het slim om details te checken voordat je iets tekent of toezegt. Minder tegelijk doen geeft vanzelf meer overzicht.

KREEFT 22 juni - 22 juli
Je behoefte aan veiligheid groeit, maar die krijg je niet door alles krampachtig vast te houden. Deze periode vraagt om helder te zijn over wat jij nodig hebt. Op werk doe je er goed aan je grenzen aan te geven, zonder je daar schuldig over te voelen. In relaties helpt het om verwachtingen uit te spreken voordat ze zich opstapelen. Kijk financieel eens naar de kleine, terugkerende kosten. Rust begint met jezelf serieus nemen, Kreeft.
LEEUW 23 juli - 22 augustus
Je voelt de drang om naar voren te stappen en initiatief te nemen. Dat werkt in je voordeel, zolang je ook ruimte laat voor anderen, Leeuw. Op werk kan samenwerken je verder brengen, dan alles zelf willen blijven trekken. In relaties gaat het om de balans tussen aandacht vragen en aandacht geven. Financieel ontstaat er heel veel lucht als je bewust kiest waar je geld naartoe gaat.
MAAGD 23 augustus - 23 september
Je hoofd klaart op en ineens zie je precies waar het rommelt. Dit is de tijd om dingen af te ronden en op te ruimen. Op werk helpt het om je prioriteiten scherp te zetten en niet alles tegelijk te willen verbeteren, hoe verleidelijk dat ook is. In relaties mag je wat minder analyseren en wat vaker denken: het is zo ook goed. Verder is dit een goed moment om overzicht te maken en overbodige kosten te schrappen. Scheelt geld én kopzorgen.
WEEGSCHAAL 24 september - 23 oktober
Je zoekt balans, maar deze periode dwingt je tot keuzes. Twijfelen mag, blijven hangen niet. Op werk loopt het beter als je helder bent over je rol en niet overal tussenin gaat staan. In relaties kom je verder door uit te spreken wat je echt wilt, ook als dat even schuurt. Dit is het moment om knopen door te hakken. Evenwicht ontstaat niet vanzelf, soms moet jij zelf de lijn trekken.
BOOGSCHUTTER 23 november - 21 december
Je blik staat vooruit, Boogschutter. Plannen maken geeft je enorm veel energie, maar deze tijd vraagt ook om nuchterheid. Op werk win je meer met kiezen dan met alles openhouden. In relaties telt echte aandacht zwaarder dan mooie praatjes of beloftes die je toch niet waarmaakt. En soms is een avondje Netflix op de bank precies goed. Je hoeft niet altijd indruk te maken.
STEENBOK 22 december - 20 januari
Je voelt de neiging om orde te scheppen en knopen door te hakken. Deze periode helpt je als je duidelijk laat zien wat je doet en waar je voor staat. In relaties wordt het lichter zodra je niet alles zelf wilt dragen, Steenbok. Kijk ook even kritisch naar je huishoudboekje en maak een heldere planning, zodat je later niet schrikt van onverwachte kosten. Blijf gaan voor je doelen, maar sta ook eens wat vaker stil bij wat je al hebt bereikt.
WATERMAN 21 januari - 19 februari
Je merkt dat er ruimte ontstaat om het anders aan te pakken. Oude gewoontes verliezen hun vanzelfsprekendheid, Waterman. Op je werk kan een idee dat al een tijdje in je hoofd zit eindelijk concreet worden. In relaties werkt oprechtheid beter dan een grapje om de boel te maskeren. Liefde voelt pas echt goed als de basis klopt. Blijf je eigen koers varen, ook als die net even anders uitpakt dan je dacht. Vertrouw op je instinct!
VISSEN 20 februari - 20 maart
Je voelt de energie terugkomen. Je intuïtie is scherp, maar vraagt wel om duidelijke grenzen. Het werkt als je creativiteit koppelt aan een beetje structuur. In relaties helpt het om helder te houden wat van jou is en wat niet. Financieel is dit een goede periode om plannen concreet te maken. Vaste momenten en kleine gewoontes geven rust. Dromen zijn mooi, Vissen, maar om ze te realiseren, heb je ook een plan van aanpak nodig.























Schaam je er niet voor, stel je vraag aan Lieve. Ze helpt je! lieve@dend.nl.



Hoi Lieve,
Schaam je er niet voor, stel je vraag aan Lieve. Ze helpt je! lieve@dend.nl.

erbij, gewoon alles. Nu appt zij dat ze me komt opzoeken om me een klap te geven, terwijl hij doet alsof ik een gestoorde stalker ben die zijn gezin kapot maakt. Hoe moet het nu verder?
P., uit H.
Ik had iets met een getrouwde man en ik wist dat het fout was, dus bespaar me de preek. Toen ik ermee stopte, draaide hij door. Met nachtelijke appjes en spraakmemo’s, en elke keer als ik hem blokkeerde kwam hij via een ander nummer terug. Op een dag was ik zo klaar met zijn geheim dragen dat ik alles naar zijn vrouw heb gestuurd. Screenshots met data
Hoi Lieve, Mijn man is al een tijd afstandelijk. Eerst dacht ik: stress. Tot hij ineens met een masker kwam in bed. Eerst vond ik het nog spannend, maar nu wil hij bijna alleen nog seks als ík zo’n bunny-masker draag.
Dat zijn vrouw je wil opzoeken is heftig, maar niet vreemd. Jij bent bereikbaar, hij niet. Dus jij krijgt de woede, terwijl hij thuis zit te doen alsof hij een slachtoffer is van twee hysterische vrouwen. Jij hoeft dit niet te fixen, of een morele discussie te voeren. Hou afstand, reageer nergens op, bewaar alles. En als hij ineens weer lief komt doen of ‘netjes wil afsluiten’, niet intrappen. Dat is geen afsluiten, dat is controle. Hij gebruikte je eerst voor spanning, nu voor schadebeperking.

Hij zegt dat hij dan ‘meer durft’. Ik voel me juist weggeduwd, alsof hij liever met een idee vrijt dan met mij. Soms doe ik mee om hem een plezier te doen, maar ik begin het wel een beetje beu te worden. Wat moet ik hiermee. Anoniem
Een masker kan spannend zijn, maar als jij het moet dragen, voelt het meer als verstoppen dan als
spelen. Dan hoeft hij jou niet echt aan te kijken, en dat voel jij. Jij bepaalt dus ook mee: soms wel, soms niet. Als hij zonder masker meteen afhaakt of gaat mokken, is het geen voorkeur meer maar een eis. Vraag hem waarom jij dat masker op moet, en wat er misgaat als je het afzet. En zeg wat het met jou doet. Als hij dat gesprek niet wil en jij je na afloop rot voelt, gaat het niet om het masker, maar om afstand.
Betaalde pikante inhoud, dus seksueel getinte foto’s en video’s waar je voor betaalt, vaak met persoonlijk contact met de maker, wordt allang niet meer vooral laat op de avond bekeken Nieuwe geanonimiseerde cijfers van friends2follow (F2F.com) laten zien dat het gebruik in 2025 juist piekt tijdens kantooruren, vooral tussen 12.00 en 18.00 uur. Dinsdag en donderdag zijn het drukst, met een duidelijke piek rond 14.00 uur en nog eentje later op de middag. Gemiddeld blijft iemand twaalf minuten per keer hangen, soms twintig minuten. In totaal gingen er vorig jaar 70 miljoen directe berichten heen en weer tussen makers en fans.
OOK EEN SEKSTIP?
Mail naar: lieve@dend.nl

Beste Lieve, Mijn moeder stuurde me een screenshot van mijn vriendin op Tinder, met nieuwe foto’s en een profieltekst die er gewoon te vers uitziet. Ze zei meteen dat het een oud account is dat blijft hangen en noemde me jaloers, maar ik voelde aan alles dat het niet klopt. Sindsdien doet ze ook raar met haar telefoon, altijd omgedraaid, altijd mee naar de wc, en als ik er iets van zeg, ben ik jaloers of moeilijk. Ik word er misselijk van, want ik wil niet veranderen in iemand die gaat speuren en checken. Maar ik wil ook niet voor een sukkel doorgaan. Hoe kom ik achter de waarheid zonder mezelf gek te maken?
A.

‘Ze noemt me jaloers, maar ik voel aan alles dat het niet klopt’


, altijd naar de word wil nd . Maar ukkel hter
Nieuwe foto’s en een verse profieltekst zijn geen ‘oud account dat blijft hangen’. Dat is iemand die z’n profiel bijhoudt. En dat zij jou daarna jaloers of moeilijk noemt, is niet per se een bewijs, maar wel een bekende truc: jij gaat twijfelen aan jezelf, en zij hoeft niks uit te leggen. Je hoeft geen detective te worden, maar je moet wel één keer duidelijk zijn. Vraag haar om het meteen te laten zien:




profiel openen, verwijderen, klaar. En vraag haar ook waarom zij daar überhaupt nog op stond met die nieuwe foto’s. Als ze gaat draaien, boos wordt of jou de schuld geeft, dan heb je ook je antwoord. ■











wát en waarom
Verzamelen is de allergrootste hobby van Nederland. Miljoenen landgenoten vinden het leuk om een verzameling aan te leggen van de meest uiteenlopende zaken. Van inderdaad postzegels, Poképonkaarten, voetbalshirts, landkaarten, vlaggen en andere ditjes en datjes. Verzamel je ook? Zet dan een gratis oproep in DenD. Mail naar: post@dend.nl.
Is er iemand die nog roos naaipatronen heeft? Helaas zijn ze niet meer te koop. Ik zoek vooral nr. 5006 en 2061, maar andere zijn ook welkom.
Monique Soeter Kempermanstraat 18 7071 XM Ulft soetermonique@gmail.com























Ik verzamel al jaren modellen van de Volkswagenbus T1. Ook andere items daarvan zijn welkom. Misschien heeft u wat staan dat u gratis tegen verzendkosten weg wilt doen. Jan Righarts jrigharts@kpnmail.nl


Ze waren ooit overal: op tv, in de bladen, op rode lopers met kapsels waar geen krul verkeerd zat. En toen: stilte.
In onze rubriek Was dat niet die van…? duiken we in het post-glamourleven van vergeten sterren. Deze maand: BERDIEN STENBERG (68)...
Berdien Stenberg was in de jaren 80 en 90 het bewijs dat je met een dwarsfluit een popster kunt worden. Ze brak door met Rondo Russo, scoorde een nummer 1-hit en zag de gouden en platina platen zich opstapelen. Later zei ze dat ze nog steeds kan leven van dat ene 'roze plaatje'. Onlangs won ze de auditie bij Het MAX Orkest, wat gemopper opleverde omdat een professional niet tussen amateurs zou horen. Daarnaast was ze twee jaar wethouder in Almere, deed in 2019 mee aan Expeditie Robinson en schreef open over haar ziekte in Hallo allemaal,mijn moeder die is kaal. In 2008 werd bij de fluitiste borstkanker met uitzaaiingen vastgesteld. „Opeens was het knobbeltje daar en het was direct goed fout”, vertelt ze. Ze keek de dood in de ogen, maar overleefde de ziekte. Haar belangrijkste levensles? „Leef! Vandaag is vandaag,nu duurt maar even,en morgen is nog maar de vraag.”





Wie maakt mij blij met een babybijtring met daaraan een rammelaar? Ik heb al een verzameling van ca. 25 stuks.
Pieta Hokken w.hokken@upcmail.nl(Sliedrecht)







Mijn zoon werkt bij de ING in Oostenrijk en is gek op stropdassen. Nu kwam ik erachter dat toen hij geboren werd er stropdassen van de ING waren (2001). Wat zou hij hier ontzettend blij mee zijn. Wie heeft ze nog ergens diep in een la liggen of in de kast hangen? Je zou hem er zo’n plezier mee doen. E. Graner e.graner@hotmail.com
NYL S yj g ammelaar? an ca. 25 stuks. liedrecht) mail.nl r

Voor mijn verzameling vinyl singles ben ik op zoek naar piraten muziek. Ook Engelstalige muziek is welkom. Heeft u nog iets liggen en doet u er niets meer mee, ik zou er heel blij mee zijn.

Sylvia Szelech Morgan
Blauwe Reiger 4 4872SN Etten Leur Wallboxsmr@hotmail.com







1 ADVOCAAT VAN DE ONDERWERELD (NPO Start)
2 REALITY CHECK: INSIDE AMERICA’S NEXT TOP MODEL (Netfl ix)




3 THE DEATH OF BUNNY MUNRO (SkyShowtime)
Podcast van de maand ***
















Elke week één stem, één waargebeurd verhaal. Rauw en eerlijk, zoals het was. Over geheimen, schaamte en de momenten waarop alles kantelt.



















Mijn moeder verzamelde oud blikken speelgoed. Ik heb het van haar overgenomen en aangevuld.

Als u wilt reageren op de verhalen in DenD, of als u iets speciaals zoekt voor uw verzameling, dan kan dat via het volgende e-mailadres: post@dend.nl
Ga voor oplossingen van de puzzels naar: ditjesendatjes.nl/puzzel en voor de prijzen naar: ditjesendatjes.nl/winnen
Ons redactieadres voor brieven en kaarten is: DenD
Donauweg 10 1043 AJ Amsterdam h
Ria Hordijk hordijk4@gmail.com



























































van de MAAND








door Marieke van der Burgt
Gedragstherapeut voor honden
In Nederland heeft zeker de helft van de honden overgewicht, terwijl de meeste baasjes ervan overtuigd zijn dat hun viervoeter een gezond gewicht heeft. Uit onderzoek blijkt dat 86 procent van de eigenaren hun hond als slank inschat, maar dierenartsen, voedingsdeskundigen en gedragstherapeuten zien dat anders.

Eindelijk heeft Xess Xava de hond die hij al zo lang wilde.

Xess Xava, de zoon van Yolanthe Cabau en Wesley Sneijder zag op zijn tiende verjaardag zijn grootste wens in vervulling gaan: een puppy. Yolanthe verraste haar zoon in het park, waar op een picknickkleed een grote doos lag. Toen Xess Xava het deksel optilde en een klein hondje hem aankeek, vroeg hij verbaasd: 'Is deze van ons?' Het hondje kreeg vrijwel direct een naam: Popcorn. Op Instagram noemde Yolanthe het later de ‘beste dag van zijn leven’ en schreef ze dat zijn reactie onbetaalbaar was en dat het voelde als een klein wonder. Veel kritiek volgde onder een bericht op Xess’ Instagram waarop hij aan het voetballen is met Popcorn, die een jasje draagt. Dat detail viel veel volgers op. 'Waarom dat pakje?' vraagt iemand. Een ander schrijft: 'Het is een hond en geen pop. Honden dragen geen kleren.' Maar voor Xess telt vooral dat ene feit: de hond waar hij al jaren van droomde, is eindelijk van hem.
Het probleem ontstaat vaak door voeding. Naast de dagelijkse maaltijden krijgen honden regelmatig snacks, van blokjes kaas tot speciale hondensnoepjes. Voor veel baasjes is het lastig om de smekende blik van hun hond te weerstaan. Overgewicht heeft grote gevolgen voor de gezondheid. Net als bij mensen vergroot het de kans op gewrichtsproblemen, hart- en vaatziekten, diabetes en huidklachten.
Erfelijke aanleg
In stedelijke gebieden hebben honden bovendien vaak minder ruimte om te bewegen. Bij rassen zoals





Een gezond voedingspatroon is de basis voor het ideale gewicht van je hond. Kies brokken of vers voer waarin dierlijke eiwitten het hoofdingrediënt zijn en vermijd producten die voornamelijk uit granen of vulstoffen bestaan. Let ook op het vetgehalte en de toevoegingen. Snacks mogen, maar bewust en met mate. Kies bij voorkeur gezonde alternatieven zoals stukjes wortel of komkommer. Vraag bij twijfel advies aan een dierenarts of voedingsdeskundige om zeker te weten dat je hond de juiste voeding krijgt.




DenD-Dierenwereld werkt samen met





Een gezond voedingspatroon is de basis voor het gewichtideale van je hond
de Labrador retriever en de Beagle speelt erfelijke aanleg een rol. Ze hebben van nature een enorme behoefte aan voedsel, waardoor ze op straat vaak extra proberen binnen te krijgen of thuis eten stelen.
Bewustwording is de eerste stap. Veel eigenaren weten niet precies wat gezonde hondenvoeding inhoudt of hoeveel hun hond nodig heeft. Een eenvoudige vuistregel: de ribben moeten goed voelbaar zijn, zonder een dikke vetlaag. Porties afmeten, kritisch omgaan met tussendoortjes en zorgen voor voldoende dagelijkse beweging zijn cruciale maatregelen. Een hond met een gezond gewicht heeft meer energie, beweegt gemakkelijker en geniet van een langere, vitale levensduur. ■
Veel honden krijgen ongemerkt te veel voer, omdat eigenaren de hoeveelheden niet nauwkeurig afmeten. Gebruik daarom een maatbeker of weegschaal en vergelijk dit met de richtlijnen op de verpakking. Houd er rekening mee dat je je hond minder geeft als er wordt getraind waarbij met voedsel wordt beloond. Een minder actieve hond heeft vaak minder voer nodig. Geef niet zomaar extra’s aan tafel, hoe verleidelijk de vragende ogen ook zijn. Door consequent te zijn voorkom je overgewicht.





Dit is Boef. Het is een Pembroke Welsh Corgi, met pootjes van tien centimeter en het zelfvertrouwen van een herder. Buiten schiet hij laag over het gras. Je ziet alleen nog een wiebelend achterwerk en twee rechtopstaande oortjes die soepel de bocht nemen. Hij is gek op paardenbloemen en hapt er altijd eentje mee alsof hij een trofee heeft gewonnen. Binnen doet hij alsof hij compleet uitgeput is. Dan ploft hij neer, zucht overdreven hard en kijkt ons aan met zo’n blik van: wat een dag weer. En elke avond rond acht uur zit hij voor het raam. Alsof hij buurtwacht is. Niemand komt hier langs zonder dat Boef het heeft gemeld.

Marleen

Ook met uw huisdier in DenD? Mail naar post@dend.nl




Beweging is belangrijk om een hond gezond en slank te houden. Een rondje om het blok is vaak niet genoeg; honden hebben afwisseling en intensievere activiteit nodig. Laat je hond regelmatig loslopen op plekken waar dat veilig kan, zodat hij kan rennen, spelen en zijn energie kwijt kan. Combineer wandelingen met spelvormen zoals apporteren of zoekspelletjes die ook mentaal uitdagen. Zeker bij honden met aanleg voor overgewicht is dagelijks bewegen de sleutel tot een langer en vitaler leven. tinleygedragstherapie.nl




















































































ZWAT KRIJG JE
ALS JE EEN KOE MET EEN TRAMPOLINE KRUIST?






ilveren Griffel-winnaar Marijn Backer schreef een spannend en fantasierijk verhaal vol mysterie en avontuur. Kees en zijn vrienden mogen naar een superbijzondere school midden in het bos. Maar al snel blijkt dat deze nieuwe school allesbehalve normaal is. Er zijn strenge regels en contact met thuis is verboden. Kees is vastberaden: deze school moet verboden worden! Maar hoe? Kees kan niemand vertrouwen. En in het bos zwerven wolven rond. Na een bloedstollende wolvenproef bedenkt Kees een gevaarlijk plan... Een verhaal over moed, vindingrijkheid en het lef om regels te doorbreken. Met sfeervolle illustraties van Sophie Pluim. Voor lezers van negen tot twaalf jaar die houden van spanning, geheimen en onverwachte wendingen.

Wat als je favoriete cartoon ineens jouw stem krijgt? Het overkwam de achttienjarige Robin van der Niet. Zij spreekt Darwin in, een van de hoofdpersonages uit De Onwaarschijnlijk Waanzinnige Wereld van Gumball, waarvan sinds kort nieuwe afleveringen op HBO Max te streamen zijn. „Ik keek de serie vroeger zelf. Dat ik nu Darwin mag inspreken is een kinderdroom die uitkomt.” Volgens Robin is nasynchronisatie, of dubbing, een sport: je spreekt bestaande films en series in een andere taal opnieuw in.













n Gumball gen o keek u Dar rdro in is dubb gkg mi werk ple k, z men eer at z maa eige op HBO Max k de serie rwin mag oom die s bi juist zo leuk voor de m haar w een op druk sam le Da m e d eek n ubbing,



















„Je moet precies tegelijk praten met het beeld en de juiste emotie raken.” Bij Darwin is dat geen rustige taak. „Hij is al gesmolten, geëxplodeerd, binnenstebuiten gekeerd, geplet. Dat zijn enorm veel gekke geluiden, maar dat maakt hem juist zo leuk. Daarbij moet je wel netjes voor de microfoon blijven staan.” Naast haar werk als stemacteur volgt Robin een opleiding tot acteur. Dat is best druk, zeker als opnames en lessen samenkomen. „Het is intensief, maar ik leer er ontzettend veel van.”
Dat zij achter Darwin zit, hebben maar weinig mensen door. „Mijn eigen stem klinkt totaal anders.”











VAN TANJA VAN

























Uitgever: MegaBlue
Leeftijd: vanaf 5 jaar | Spelers: 2-4








Bij ValliBalli draait alles om een vaste hand en concentratie. Tijdens je beurt pak je een kraal uit je eigen gootje en schuif je die op het uiteinde van je stokje. Vervolgens probeer je de kraal voorzichtig boven op de tros gekleurde ballen te leggen. Trek daarna je stokje rustig weg, zonder dat alles instort. Daarna is de volgende speler aan de beurt. Wie als eerste al zijn kralen kwijt is, zonder dat de stapel omvalt, wint. ValliBalli is een erg leuk behendigheidsspel voor het hele gezin. Jonge kinderen zullen het spel waarderen vanwege de eenvoudige regels en de vrolijke, felle kleuren. Oudere kinderen ontdekken al snel manieren om hun kralen slim kwijt te raken en ruimte voor andere spelers te blokkeren. Ook met volwassenen is het een leuk spel, zeker als de spanning oploopt. Er zijn verschillende moeilijkheidsniveaus voor extra uitdaging. Insta: boardgame_review_tanja






Score: ✪ ✪ ✪ ✪ ✪







Drie koeien staan in de wei. Zegt er eentje: „Woef woef”. Vraagt de ander verbaasd: „Wat doe jij nu?” Zegt de eerste koe: „Ik studeer vreemde talen!”

De woorden hieronder zitten in alle richtingen verstopt. Sommige letters kunnen vaker gebruikt worden. Streep alle woorden af die je hebt gevonden. De letters die overblijven, zet je achter elkaar in de lege hokjes. Dat is de oplossing.

CHOCOLA
CLOWN
DANSEN
FEEST
HOERA
JARIG
KAARSJES


LACHEN OOM
OPA
PATAT
PRETPARK
RANJA
SLINGERS

SPEELTUIN
SPELEN
TAART
THEE
TRAKTATIE
VLAG
ZUS









In de gloednieuwe afleveringen van De Onwaarschijnlijk Waanzinnige Wereld van Gumball op Cartoon Network en HBO Max beleven Gumball en Darwin weer de vreemdste avonturen in het stadje Elmore. Zo probeert Gumball de moeilijkste fietstocht ooit te overleven, raakt Darwin verstrikt in een nogal vreemde machtsstrijd en duikt er een mysterieus dagboek op dat voor allerlei geheimen zorgt.




DenD verloot een knotsgek Gumball-pakket. Stuur je oplossing van de woordzoeker in op ditjesendatjes.nl/puzzel om kans te maken.





Deze armband met zachtroze satijnkoord en een 14 karaat gouden hartje is zo’n sieraad dat je zonder nadenken omdoet en de hele dag laat zitten. Dankzij de verstelbare lengte van 13 tot 26 centimeter past hij vrijwel altijd. De armband is afkomstig van Maxgoud, gevestigd aan de Admiraal de Ruyterweg 16a in Rotterdam. Het bedrijf kreeg landelijke bekendheid door de undercovertest van VARA Kassa, waarin het de hoogste goudprijs bood. Inmiddels heeft Maxgoud meer dan 500 positieve reviews verzameld. maxgoud.com

Sir Winston Fun & Games heeft meerdere arcadehallen door heel Nederland. In elke vestiging vind je een indrukwekkend spel-aanbod: van behendigheidsspellen tot klassieke arcadegames. Je kunt er highscores neerzetten, tickets verzamelen en coole prijzen winnen. Ook kun je terecht voor toffe kinderfeestjes en bedrijfsuitjes die je volledig naar wens kunt samenstellen. Met locaties in Rijswijk, Schiedam, Scheveningen, Ypenburg, Amsterdam en Zaandam. sirwinstonfungames.nl

WINNEN!
DenD verloot een Sir Winston Fun & Games-prijs met 3 gymtassen, 60 tickets (voor de spellen/prijzenmuur), 3 knuffeldiertjes en 30 minuten gratis gamen voor 3 personen. Stuur de oplossing van de puzzel in op ditjesendatjes.nl/puzzel om kans te maken.



Licht als vleugels en helder als hoop; deze elegante oorstekers zijn geïnspireerd op de kleinste vlinders. Met fijne precisie vervaardigd voegen de Trollbeads Fladder Oorknoppen een subtiele en verfijnde sprankeling toe aan alledaagse momenten. Een tijdloos sieraad dat elegantie en zachtheid perfect combineert. juwelierjansen.nl
WINNEN!DenD verloot deze Trollbeadsoorknoppen. vanStuurdeoplossing depuzzelinop ditjesendatjes.nl/ puzzel om kans te maken.


„Het breien is leuk, maar de gezelligheid is nog veel belangrijker. Je voelt je gezien”, zegt mevrouw Van Dijk (82). Voor veel ouderen is contact niet meer vanzelfsprekend. Als je minder mensen ziet, kan een gevoel van eenzaamheid snel toenemen. Een simpele wekelijkse ontmoeting kan dan het verschil maken.
Met Samen Breien brengt het Nationaal Ouderenfonds ouderen bij elkaar om te breien, verhalen te delen en nieuwe vriendschappen op te bouwen. In buurthuizen en wooncentra door het hele land ontstaan warme, veilige plekken waar ouderen zich welkom voelen. De breiclubs worden ondersteund door toegewijde vrijwilligers en laagdrempelige activiteiten, waardoor iedereen kan meedoen.
Sterkste middel
In Nederland voelen 1,8 miljoen ouderen zich eenzaam. Het Nationaal Ouderenfonds brengt



ouderen met elkaar én met de maatschappij in contact. Hun overtuiging is helder: verbinding is het sterkste middel tegen eenzaamheid. Het fonds zegt het zelf zo: ‘Eenzaamheid los je niet op met één gesprek, maar met blijvend contact.’ Met projecten zoals Samen Breien, de PlusBus en OldStars-activiteiten brengen zij ouderen weer onder de mensen. ouderenfonds.nl ■
Van 13 april tot 17 mei zetten alle Dirk filialen zich in voor het Nationaal Ouderenfonds. Tijdens deze periode vind je bij het flesseninleverpunt een speciale donatiebox. Door jouw statiegeld te schenken, help je mee om meer breigroepen te starten en ouderen samen te brengen voor gezellige ontmoetingen. Wil je zelf meedoen of iemand aanmelden? Kijk op: ouderenfonds.nl/samenbreien































































De nieuwe DenD verschijnt eind april Droomreis door Tanzania










DenD en Oranje Boven zijn de grootste gratis redactioneel onafhankelijke familiebladen van Nederland met een oplage van 650.000 exemplaren. Gratis meenemen bij de meer dan 130 supermarkten van Dirk van den Broek en 44 Dirck3-slijterijen.
Ga naar www.dend.nl voor het actuele entertainment- en royaltynieuws.
Uitgever
Brookland Productions, Sassenheim
Concept, realisatie en redactie
Trusted Media Publishers
Fotografie
Johannes Dalhuijsen, ANP/ Hollandse Hoogte o.a.: Edwin Jansen, Anneke Jansen, Patrick Harderwijk en Robin Utrecht, Flickr, Unsplash, Instagram, Facebook, Netflix, Jurjen Donkers



Adres redactie DenD
Trusted Media Publishers






















Donauweg 10 1043 AJ Amsterdam
DenD wordt verspreid via: alle Dirk van den Broek-supermarkten en Dirck3-slijterijen
Niets in deze uitgave mag, in welke vorm en op welke wijze dan ook, worden overgenomen zonder voorafgaande schriftelijke toestemming van de uitgever. Hoewel DenD met de grootst mogelijke zorgvuldigheid wordt samengesteld, staan uitgever en redactie niet in voor eventuele onvolkomenheden in de inhoud en kunnen hiervoor niet aansprakelijk worden gesteld. Niet alle in de advertenties genoemde producten zijn verkrijgbaar in de winkels die hieronder worden genoemd.






Alysi: eu.alysi.com
Essential Antwerp: essentiel-antwerp.com/nl_nl
Mart Visser: martvisser.nl
Mou: mou-online.com
Part Two: parttwo.com/nl
Unisa: unisa-europa.com/nl





























































